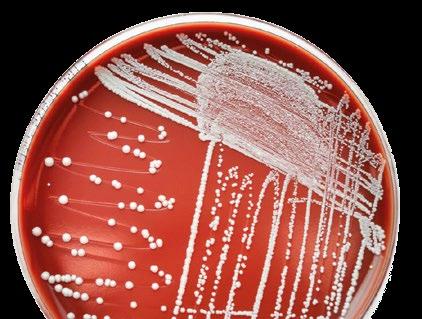

06
Manejo y mantenimiento de los equipos automáticos en naves avícolas: bebederos
Francisco Castellanos Guzmán1 y José Antonio Quintana López 2
1 Consultor avícola
2 DMZA FMVZ UNAM
18
Evaluación de la salud intestinal en avicultura: Biomarcadores y aplicaciones
Óscar Mencía Ares



DVM PhD. Veterinario – Área I+D del Departamento de Diagnóstico de Exopol s.l.
Llegó el calor: una visión actualizada (Parte III)
Gonzalo Arellano Peche Veterinario Consultor Avícola
38
La importancia del análisis de los datos de embriodiagnosis para la gestión de la planta de incubación

Renata Steffen Consultora en incubación industrial

53
Avícola Larrabe apuesta nuevamente por el sistema Bolegg Gallery
Equipo Técnico Vencomatic Ibérica
58
Entendiendo la luz en avicultura: Guía del uso de las luces LED para ayudar a los productores de huevo
Equipo Técnico Hy Line
¿Qué
Evolución de la prevalencia de Salmonella desde 2017 hasta 2022 88

Cristina García Bover1 y Pablo Catalá Gregori2 1Coordinadora y Resp. Calidad CECAV
2Director gerente CECAV


El Grupo de Comunicación Agrinews quisiera resaltar y distinguir el notable empeño y apreciable aporte y colaboración de los autores de los artículos. El esfuerzo compartido hace posible que podamos ofrecer a nuestros lectores un contenido técnico de calidad. Reiteramos por tanto nuestro más sincero agradecimiento.
A medida que crece la demanda de animales criados de manera más sostenible, también lo hace el rendimiento de nuestros ingredientes eficientes de máxima calidad y nuestras innovadoras soluciones digitales.
Ácidos orgánicos
Ácido linoleico conjugado
Aditivos anti-micotoxinas

Carotenoides

Enzimas
Glicinatos
Monoglicéridos
Propandiol
Vitaminas
Soluciones digitales: OpteinicsTM – Software para una producción más sostenible y cálculo del impacto medioambiental trinamiX – Espectroscopía
NIR portátil
Cloudfarms – Sistema de gestión porcina

The science of sustainable feed that succeeds



Efectivo y específico para aves
Simbiótico que contiene múltiples cepas
Patentado y registrado en la UE
Permitido en la producción orgánica
Sin riesgo para la salud de los animales o humanos
Si no somos nosotros, ¿quién?
Si no es ahora, ¿cuándo?
WE MAKE IT POSSIBLE
No son buenas noticias las provenientes de un informe elaborado por McKinsey y la patronal Eurocommerce que dice que los consumidores españoles dan prioridad al precio sobre la calidad en las compras.

Desgraciadamente, la pandemia por el COVID ocasionó un cambio en el pensamiento de la población europea y, por supuesto, en la española. Si además, añadimos el agravamiento de la situación económica de muchos ciudadanos que no llegan a fin de mes y de la elevación de la inflación que ha encarecido sobre todo la cesta de la compra alimenticia, puede encontrarse una justificación en el cambio de prioridades a la hora de comprar.
Estos motivos pueden ser los causantes por lo que los consumidores españoles estén a la cabeza y superen a la media de estos en los grandes países europeos. Al 60 % de los consumidores españoles les preocupa el precio de los productos que compran, y sólo un 17 % prioriza la calidad.
Cuando hay crisis económica, los consumidores tienden a comprar productos más baratos, normalmente asociados a marcas blancas.
Otra consecuencia de las crisis económicas es que para el consumidor que busca precio barato, además de no importarle la calidad, es que tampoco le importa el origen del producto que compra, aspecto muy preocupante en el sector avícola por la posibilidad de incrementar los costos por medidas más restrictivas de bienestar animal. Seguramente, se procederá a la importación de productos de terceros países con menos costes de producción y con menores requisitos de bienestar animal, que harán disminuir el coste de la cesta
de la compra a los ciudadanos europeos en unas compras imprescindibles de una proteína animal exquisita, necesaria y barata.

La situación global está haciendo cambiar el mundo y nuestras costumbres. Si antes se gastaba un 40% del sueldo en alimentación, ahora se ha reducido a un 25%, lo que provoca menos dinero para agroalimentación.
Pero otra consecuencia, peor aún, es que estamos acercándonos al final de la cultura de la vida mediterránea. Estamos cambiando nuestro modo de vida y nos dirigimos a un estilo de vida más solitario. Crece el teletrabajo, se incrementa el auge por el metaverso, la cultura y el ocio se están virtualizando. Todo ello hace que seamos menos sociables y más individualistas.
Nos están introduciendo sin darnos cuenta costumbres, sobre todo del mundo anglosajón, en que no se disfruta del momento de comer, convirtiéndolo en algo rápido y solitario.
Ante todo esto, debemos hacer un punto de inflexión, pues nos jugamos nuestra calidad de vida mediterránea - tan deseada por la mayoría de los ciudadanos del mundo -.
Defendamos el origen de nuestros productos y preservemos el modo de vida de muchos ciudadanos que hacen posible que con su trabajo en el medio rural podamos tener productos de calidad y asequibles, que nos permitan seguir viviendo con una calidad de vida envidiable por los demás países. Disfrutemos de nuestras comidas y cenas con otras personas, abandonando las prisas y la soledad.
¡Defendamos nuestros productos, para conseguir que no desaparezca nuestro estilo de vida mediterráneo!
GRUPO DE COMUNICACIÓN AGRINEWS S.L.
PUBLICIDAD
Luis Carrasco +34 605 09 05 13 lc@agrinews.es
Félix Muñoz +34 618 18 00 16 felix@mediatarsis.com
DIRECCIÓN TÉCNICA
José Luis Valls
REDACCIÓN
Osmayra Cabrera
Gerard Ponz
F.X. Mora
Daniela Morales
COLABORADORES
Juan Carlos Abad
José Ignacio Barragán
Luis Canela
Serafín García Freire
Edgar Oviedo Rondón
Juan Carlos López
Mike Czarick
Santiago Vega
Eduardo Cervantes
Gonzalo González Mateos
Barcelona - España
Tel: +34 93 115 44 15 info@agrinews.es avinews.com
Precio de suscripción anual:
España 36 €
Extranjero 125 €
DIRIGIDA A VETERINARIOS Y TÉCNICOS
Depósito Legal aviNews B11597-2013
ISSN (Revista impresa) 2696-8061
ISSN (Revista digital) 2696-807X
Revista bimestral
La dirección de la revista no se hace responsable de las opiniones de los autores.
Todos los derechos reservados. Imágenes: Noun Project / Freepik/Dreamstime
1 Consultor avícola
2 DMZA FMVZ UNAM
El agua es el líquido vital para la supervivencia y desarrollo. Es el solvente universal, interviene en las reacciones de combustión de los nutrientes, es el vehículo de transporte de nutrientes y desechos celulares.

Además de ser el alimento más barato, el cuerpo de las aves jóvenes está compuesto por el 70% de agua, pero si pierden el 20% se mueren.
Por esto es de suma importancia el consumo adecuado. Es más, el consumo de agua es el doble del consumo de alimento y se puede incrementar si la temperatura ambiente aumenta.
 Francisco Castellanos Guzmán1 y José Antonio Quintana López2
Francisco Castellanos Guzmán1 y José Antonio Quintana López2
Del porcentaje total de agua en la tierra (Figura 1), el 2,5% es de agua dulce, donde el 0,75% está en forma líquida en ríos, lagos, lagunas y en el subsuelo y el 1,75% está congelada en los polos.

Si los polos se continúan descongelando por el cambio climático se perderían algunas poblaciones costeras por inundación.
Los animales jóvenes tienen entre 55% y 80% de agua corporal y los adultos solamente el 60% y el huevo el 65%. El agua es indispensable para la producción pecuaria.
PORCENTAJE DE AGUA EN LA TIERRA
Agua total 70% Tierra 30%
Salada 97,5% Dulce 2,5%
Congelada 70% Líquida 30%
Todas las casetas deben tener un caudalímetro (Imagen 1) para poder llevar un control del consumo de agua.

El caudal se expresa en metros cúbicos, 1 m³ equivale a 1000 litros. En general las aves beben el doble del consumo de alimento y puede cambiar con la temperatura.
Para un buen consumo de alimento el rango de temperatura del agua de bebida para las aves debe estar entre 18°C y 25°C.
 Figura 1. Porcentaje de agua en la tierra
Imagen 1. Caudalímetro.
Figura 1. Porcentaje de agua en la tierra
Imagen 1. Caudalímetro.
Cuando se van a instalar bebederos de tetina:
Lo primero que hay que hacer es revisar el desnivel del piso de la nave.
Es muy importante saber que un solo regulador de presión es para una sola línea de 100 m y un desnivel del piso del 1%,
Si la línea mide más de 100 metros se debe dividir la línea en dos secciones y se coloca un regulador por cada sección. Esto se recomienda para evitar la presurización y que las tetinas goteen y se humedezca la cama.
Si el desnivel es mayor a 1,5%, se deben medir tramos que se requieran, procurando que cada tramo no pase del 1% de declive y en cada tramo se debe instalar un regulador de presión.
Las líneas deben estar bien suspendidas y quedar paralelas al piso para evitar burbujas de aire y hacer que el agua fluya uniformemente.
Cuando el cuadro de mando (Imagen 2) se instale hay que poner atención en la dirección del flujo y tener compuertas para poder desviar el agua por donde se requiera, ya que en este cuadro se instalan los filtros y el dosificador para cuando haya necesidad de dar algún tratamiento o realizar un retrolavado.

Cuando se termine el tratamiento se recomienda dejar pasar por el dosificador cuando menos 20 lts. de agua, para lavar el émbolo y quede preparado por si se requiere otro tratamiento. De lo contrario, se queda pegado y los operadores en granja regresan a adicionarlo en el depósito y el dosificador no lo vuelven a usar.
Es muy común que en ocasiones hagan pasar el agua en forma directa sin pasar por los filtros, ya que estos pueden estar sucios y el agua pasa con poca presión. Para evitar este manejo hay que revisar los manómetros, dado que estos deben tener la misma presión de entrada y salida.

Flecha azul delgada:
Manómetros: Los dos deben trabajar a la misma presión tanto de entrada como salida del agua
Recorrido del agua para retrolavado Puntas
Imagen 2. Cuadro de mando.Ensambles para suministro para dos líneas de bebederos
Mirilla
Este proceso consiste en cerrar las compuertas para hacer pasar el agua únicamente por los filtros para que estos se laven.
Varilla Suministro de agua al regulador
Oreja para colgar la línea
Por lo cual, el agua se deja pasar y se recibe en una cubeta. El tiempo de lavado se mantiene hasta que el agua salga limpia, no hay que desmontar los filtros. Con este manejo se le da mayor vida útil al equipo.

Perilla para incrementar la presión Manivela para drenar la línea
Imagen 3. Regulador de presión
Mientras, la altura de la varilla de la mirilla de inicio y al final de la línea debe ser la misma.
Regularmente todas las tetinas son 360°C y con mucha facilidad de mover el PIN en forma vertical.



Mirilla
Manivela para flushing
Biofilm o bioplaca Pin o pivote tetina
Agua Agua
Burbujas de aire
Perilla para regular columna de agua
Diafragma
Imagen 4. Partes del regulador de presión
Imagen 5 . Corte transversal de las líneas


Todos los reguladores de presión que se colocan al inicio de las líneas tienen una manivela para enviar el agua en forma directa (drenado de la línea).
Al final de cada línea se debe tener conectada una manguera para que el agua que sea liberada por las líneas fuera de la caseta y esta manguera debe tener una altura mayor a las líneas de bebederos de 20 cm a 30 cm, cuya finalidad es que cuando no se realice el drenado, no se tire el agua dentro de la nave.


El drenado de la línea debe ser de 1 minuto por cada 30 metros de línea, este proceso se debe realizar una vez por semana para que no se forme biofilm en las líneas y no se contamine el agua y fluya con normalidad.
Ensambles de las líneas y la altura de las mirillas regularmente deben estar a la misma altura, tanto al inicio como al final de la línea (Imagen 7).
A la misma altura como se señala en la imagen anterior, los reguladores de desnivel son tres, para regular 20 cm, 15 cm y 10 cm.
Cuando las líneas están muy bajas y/o presurizadas las camas se humedecen. Como se observa en la Imagen 8
El agua se debe analizar para coliformes y sólidos totales cada 6 meses y físico-químico cada año.
Si el agua es alcalina se puede adicionar vinagre a razón de 1 litro/1000 litros de agua diariamente, esto significa que las aves pueden beber el agua tratada.
Este manejo se realiza para que no se tapen las tetinas.
 Imagen 6. Drenado de la línea.
Imagen 7. Ensambles.
Imagen 8. Camas húmedas por líneas muy bajas.
Regulador de desnivel
Señala que regularmente deben coincidir la mirilla de inicio con la del final de la línea
Varilla de la mirilla
Imagen 6. Drenado de la línea.
Imagen 7. Ensambles.
Imagen 8. Camas húmedas por líneas muy bajas.
Regulador de desnivel
Señala que regularmente deben coincidir la mirilla de inicio con la del final de la línea
Varilla de la mirilla
Los sólidos totales son la materia que permanece como residuo en el agua. Esta puede ser orgánica e inorgánica, en este caso es el agua que beben las aves.
Las líneas se drenaron hasta que saliera agua sin sólidos y se drenó el tanque elevado.
Cuadro 1. Calidad de Agua
Cómo medir el flujo agua de las tetinas
Como calcular el flujo de agua de las tetinas según la edad (Dr. Berry Lott. MSU). No se necesita mayor flujo de las tetinas, solamente que sea constante.

Fórmula para calcular los mililitros (ml) de agua/minuto que se requieren según la edad de los pollos:
Edad en días + 20 = ml/min.
Ejemplo: pollos de 7 semanas = 49 días = 49+20 = 69 ml/min.
Número de aves por Tetina
11 pollos por tetina.
Gallinas de postura 1/jaula, (jaulas para tres o 4 gallinas).
7 a 8 gallinas Reproductoras pesadas / tetina.

B C
CUADRO DE MANDO CORRECTO A A A A
A
ENTRADA
Llave de desagüe, para no mojar la cama.
Filtro de partículas gruesas
Filtro de partículas de menor calibre
SALIDA
Tubo para conexión del mediador
Tubo para entrada de agua al mediadior
Imagen 13. Cuadro de mando correcto
 Imagen 9. Copas con sólidos
Imagen 10. Colores de agua
Imagen 9. Copas con sólidos
Imagen 10. Colores de agua
En la práctica se puede usar una probeta o una botella con la que se les da leche a los bebés y una malla metálica, solo se necesita que esté graduada. Para recolectar el flujo de agua de las tetinas durante un minuto.



Imagen 11. Probeta graduada y malla metálica.
Imagen 12. Midiendo el flujo de la tetina.
Procurar que la suspensión de las líneas tenga una alineación lo más recta posible, los tirantes de suspensión se colocan cada tres metros con la finalidad de mantenerse alineada con el piso.
Si se hace la instalación en una granja con mayor desnivel del piso a 1% se deben cortar las líneas y ajustarse al desnivel que se recomienda.
De lo contrario, se presentan humedades por goteo por la presurización de las líneas causado por el mayor desnivel.
La presión en la línea está dada por estos equipos y se puede observar en la altura de mirilla que está al inicio y final de cada línea, Imagen 14.
Estas compuertas intervienen en el retro lavado: Esto consiste en hacer pasar agua a presión por la tubería y lavar los filtros sin separarlos de la línea para incrementar la vida útil. Esta operación debe realizarse una vez por semana.




Manómetro de entrada y Manómetro de salida: Estos deben de tener la misma presión tanto de entrada y salida. Si estos presentan presión diferente seguramente el filtro está sucio y requiere limpieza. En este caso se debe realizar el retro lavado, si después sigue el problema hay que desmontar los filtros.


Las alturas de las líneas (como se observa en las imágenes 15 y 16).
Manivela para drenar la línea
Manivela para regular la altura de agua en la línea
 Posición de las aves cuando están bebiendo.
Imagen 15. Altura normal
Imagen 17. Al inicio de la parvada la tetina debe de estar a la altura de los ojos.
Imagen 16. Mayor altura
Imagen 18. Altura y presión adecuada para iniciar la parvada.
Imagen 14. Reguladores de presión
Posición de las aves cuando están bebiendo.
Imagen 15. Altura normal
Imagen 17. Al inicio de la parvada la tetina debe de estar a la altura de los ojos.
Imagen 16. Mayor altura
Imagen 18. Altura y presión adecuada para iniciar la parvada.
Imagen 14. Reguladores de presión
Descubre las últimas novedades:
Propiedades desinfectantes aún más poderosas
El único biocida con registro EU-BPR en clasificación PT02, PT03, PT04 y PT05

Más sostenible y a prueba de futuro
*Intra Hydrocare tiene su propio registro EU-BPR para uso en ganadería. Con una clasificación PT05, Intra Hydrocare es el único biocida basado en peróxido de hidrógeno permitido para uso en agua potable hasta un dosis de 250 ml por 1.000 litros de agua mientras los animales están presentes. Esto hace Hydrocare único!

Pioneros en soluciones preparadas para el futuro


Este es el que se revisa todos los días y si se detecta una anomalía que no necesite personal especializado, ya que este se ejecuta con el personal de granja.
Este se debe realizar con personal especializado y ellos determinarán el daño, y se hace corregir el daño.
Este consiste en una inspección realizada por personal especializado y si se detecta algo en los equipos que no esté funcionando bien se corrige. Regularmente, se hace cuando termina la parvada.
Proporcionar agua limpia y fresca con caudales adecuados es fundamental para una buena producción avícola. Sin una ingesta adecuada de agua, el consumo de alimento disminuirá y el rendimiento de las aves se verá comprometido.


Recordar que el nutriente más importante es el agua. Esta debe ser potable, a temperatura adecuada, suficiente y al alcance de todas las aves.


Por otra parte, tener siempre presente que el realizar un buen manejo de cualquier equipo ayudará a tener mejores resultados productivos y tener mayor vida útil de los mismos.
Manejo y mantenimiento de los equipos automáticos en galpones avícolas: Bebederos DESCÁRGALO EN PDF
Imagen 19. Atura correcta.
Cuando hablamos de salud intestinal estamos refiriéndonos al correcto funcionamiento y al equilibrio del aparato digestivo y de la microbiota intestinal.
El intestino es un órgano clave para la funcionalidad del organismo de todos los animales, ya que no sólo es el responsable de la digestión y la absorción de nutrientes, sino que también constituye una primera barrera defensiva para la entrada de patógenos y sustancias nocivas para el organismo, además de desempeñar funciones inmunitarias y hormonales clave.
Asimismo, esta salud intestinal está influida por numerosos factores, como puede ser la dieta, el manejo, las condiciones de alojamiento o, incluso, la propia genética del animal.
 Veterinario – Área I+D del Departamento de Diagnóstico de Exopol s.l.
Veterinario – Área I+D del Departamento de Diagnóstico de Exopol s.l.
En la actualidad, el sistema de producción al que está sometida la producción avícola, tanto de puesta como de carne, hace que sea necesario monitorizar la salud intestinal en estos animales, con el objetivo de establecer medidas preventivas que nos permitan garantizar un adecuado funcionamiento de su aparato digestivo.

Así, por ejemplo, el empleo de determinados aditivos o probióticos durante las etapas iniciales de la vida de los pollos de engorde puede provocar modulaciones en la microbiota que se implanta en su tracto gastrointestinal.
En consecuencia, genera un impacto reseñable sobre la integridad y el estatus inflamatorio de la pared intestinal en etapas productivas posteriores.


La monitorización de la salud intestinal se puede realizar mediante técnicas no invasivas que suponen una menor manipulación, como la recogida de excretas, o técnicas invasivas, que implican una mayor manipulación del animal, como muestras de tejidos.
En el caso de la avicultura, se opta principalmente por el uso de técnicas invasivas, destacando la toma de muestras de mucosa digestiva y contenido intestinal.
El tramo del tracto digestivo a seleccionar variará en función del biomarcador a analizar. Este abordaje invasivo se debe a diferentes razones:
Una salud intestinal óptima es indispensable para una buena salud general y, en definitiva, para
Las excretas están compuestas por heces y orina. La orina puede provocar cambios sustanciales en la composición de los marcadores presentes en las heces, no haciéndolos comparables con lo detectable en el
La variedad de marcadores potenciales que se pueden monitorizar para el estudio de la salud intestinal en avicultura es muy amplia.
Todos ellos están interconectados (Figura 1), por lo que es interesante realizar un abordaje integral de diferentes grupos de parámetros para poder obtener la imagen más completa posible del efecto que determinadas intervenciones tienen sobre el tracto digestivo de las aves.
A continuación, se detallan algunos de los que tienen una mayor relevancia y aplicabilidad en avicultura de carne y de puesta.
La microbiota intestinal desempeña un papel fundamental en la salud digestiva en las aves domésticas.
Esta microbiota está constituida fundamentalmente por bacterias, pero también arqueas, virus, protozoos y hongos.
La microbiota realiza funciones beneficiosas para el organismo, como la digestión de ciertos nutrientes o la producción de ácidos grasos de cadena corta y vitaminas.
Además, promueve el desarrollo del sistema inmunitario al desafiar a las células inmunitarias presentes en la pared intestinal.
Capa mucosa
Capa mucosa interna
Bacteria
Macrófagos
Figura 1. Esquema de la interacción de la microbiota intestinal y la pared intestinal con la respuesta inflamatoria local y sistémica. Adaptado de Peng J. y col. (2021). externa Lámina própia Torrente sanguíneo


Enterobacteriaceae Familia bacteriana que incluye algunas de las especies bacterianas más perjudiciales para la salud digestiva, como Escherichia coli o Salmonella enterica
Clostridium perfringens
Lactobacillus
Bifidobacterium
Especie bacteriana residente del tracto gastrointestinal de las aves, cuyo sobrecrecimiento tiene efectos perjudiciales para su salud digestiva.
Género bacteriano beneficioso que participa en la producción de determinados compuestos, como ácidos grasos de cadena corta. Además, promueve el desarrollo del sistema inmunológico.
Género bacteriano beneficioso que participa en la producción de determinados compuestos, como ácidos grasos de cadena corta. Además, promueve el desarrollo del sistema inmunológico.
Lachnospiraceae
Familia bacteriana beneficiosa por su papel en la digestión de la fibra alimentaria y la producción de ácido butírico. Algunos géneros, como Blautia o Roseburia, son muy importantes en el control de los procesos inflamatorios en el intestino.
Sin embargo, en la microbiota intestinal existen microorganismos perjudiciales, cuyo incremento puede provocar una disbiosis intestinal – desequilibrio en las proporciones de los microorganismos – y una disminución de la capacidad defensiva del organismo.
Por consiguiente, puede traducirse en procesos digestivos, con las consecuentes pérdidas productivas.
Entre todos los componentes de la microbiota intestinal, las bacterias son los microorganismos más ampliamente estudiados para la evaluación de la salud digestiva en avicultura.

En la actualidad, existen dos abordajes principales para su monitorización en muestras digestivas:
Secuenciación masiva del gen 16S
ARNr: estudio de todas las bacterias presentes en la muestra, permitiendo no sólo cuantificar cada taxón bacteriano, sino también valorar la diversidad presente en el tracto digestivo.
Tabla 1. Taxones bacterianos de interés para la monitorización de la salud intestinal en avicultura.Cuantificación de taxones bacterianos específicos: el empleo de la PCR a tiempo real se pueden cuantificar de forma específica determinados microorganismos que puedan considerarse de relevancia por sus características beneficiosas o perjudiciales para la salud digestiva de las aves, simplificando la interpretación de los resultados y reduciendo los costes.
En la Tabla 1 se incluyen los taxones bacterianos a monitorizar en avicultura de carne y de puesta.
La composición de la microbiota intestinal es diferente en función del tramo del aparato digestivo –destacando su relevancia a nivel de íleon y, especialmente, de ciego – y si está asociada a la mucosa o embebida en el contenido intestinal.

Por tanto, el tipo de muestra a analizar para el estudio de la microbiota variará en función de los cambios esperables derivados de la intervención realizada.
De forma general, la diana de los estudios de microbiota en avicultura suele ser el contenido de íleon y de ciego.
Una adecuada unión entre las células del epitelio intestinal, junto con el mucus segregado por las células caliciformes, garantiza que la función de barrera de la pared intestinal se mantenga intacta.
En caso de disrupción de esta primera línea defensiva, se ocasiona un incremento de la permeabilidad intestinal que facilita la entrada transcelular de compuestos perjudiciales para el organismo, como sustancias tóxicas, microorganismos o sus metabolitos.
Esto desencadena una respuesta inmunitaria local mediante la liberación de precursores inflamatorios, como citoquinas, que se puede trasladar a nivel sistémico.
En la actualidad, existen dos abordajes principales para el estudio de la expresión génica en muestras digestivas:
secuenciación de todo el ARN mensajero producido por las células de la pared intestinal, permitiendo dar una imagen completa de todos los genes que se están expresando en las células de interés, realizando un estudio exhaustivo de sus interconexiones.

La monitorización de la integridad intestinal y la respuesta inflamatoria local en avicultura se basa en el estudio de la expresión génica de las células presentes en la mucosa intestinal – como enterocitos, células caliciformes y células inmunitarias – para poder valorar si estos genes están expresados en mayor o menor medida en el grupo experimental respecto a un grupo control.
Para evaluar esta expresión génica, la diana es el ARN mensajero producido por estas células, que es el material genético intermedio para la síntesis de las proteínas que van a desempeñar las funciones de integridad e inflamación.
El tejido diana para la valoración de esta expresión génica es la mucosa del yeyuno, si bien estos análisis pueden realizarse en otros tramos del tracto gastrointestinal, en función de los resultados esperables del estudio.
Su principal limitación es su elevado coste y la necesidad de disponer de un equipamiento y un personal muy especializados para poder analizar e interpretar todos los resultados obtenidos.
Mediante el empleo de la PCR a tiempo real se puede cuantificar el ARN mensajero de genes específicos que están involucrados en la salud intestinal.
En la Tabla 2 se incluyen los principales biomarcadores a monitorizar en avicultura de carne y de puesta.

Integridad intestinal
Ocludina
Zonulina-1
Producción de mucus Mucina-2
IL-1β
Proteína de unión estrecha transmembrana responsable de mantener la unión entre las células del epitelio intestinal.
Proteína de unión estrecha intracelular responsable de mantener la unión entre las células del epitelio intestinal.

Glicoproteína segregada por las células caliciformes que constituye el componente principal del mucus de la pared intestinal.
Citoquina proinflamatoria con papel fundamental en la estimulación de la respuesta inmune inflamatoria.
Inflamación intestinal
IL-10
Citoquina con función reguladora sobre la respuesta inmune, inhibiendo la síntesis de citoquinas y las funciones de determinadas células inflamatorias. pericoli.com
Tabla 2. Principales biomarcadores empleados para la monitorización de la integridad y la inflamación intestinal en avicultura.nuevos ventajas gracias a la actualización de nuestro marco en metal para la instalación de los paneles evaporativos .
Nuestro Equipo de Venta está a disposición para cualquier información adicional y para explicarle mejor en detalle todas las características del
La principal aplicación práctica de estos estudios es la evaluación in vivo del efecto que determinados aditivos administrados vía oral, como probióticos, prebióticos, aceites esenciales o ácidos orgánicos, pueden tener sobre la salud digestiva de los animales.
Así, por ejemplo, son múltiples los estudios que han evaluado el efecto de la suplementación de la dieta de las aves con el objetivo de mejorar la salud de los animales y el incremento de los rendimientos productivos, como extractos de levadura o cepas probióticas de Bacillus subtilis.
Otras aplicaciones incluyen la evaluación de determinadas intervenciones en los animales y en el ambiente, como el estrés térmico o los cambios en las condiciones de alojamiento de las aves.
En la práctica de campo rutinaria, el cambio de estrategias nutricionales a menudo se acompaña del estudio de parámetros productivos para justificar su impacto sobre los rendimientos productivos de la explotación.
Estos estudios deben complementarse con la monitorización de la salud intestinal, ya que son datos objetivos que permitirán obtener una imagen completa del efecto que se está produciendo en el organismo de los animales.
Todo ello, con un fin último: la mejora del bienestar y la salud digestiva de las aves, garantizando así una salud general y unos rendimientos productivos óptimos.

Evaluación de la salud intestinal en avicultura: biomarcadores y aplicaciones DESCÁRGALO EN PDF





 Gonzalo Arellano Peche Veterinario Consultor Avícola
Gonzalo Arellano Peche Veterinario Consultor Avícola
La temperatura óptima del agua de bebida para los pollos de carne se sitúa entre 15 y 21 ºC.

A partir de 21 ºC, el consumo de agua aumenta en 6,5 % por cada 1 ºC que aumenta la temperatura.
A partir de los 30 ºC, comienza a reducirse su consumo.
A los 42-44 ºC, los pollos dejan de beber, lo que provoca pérdida de peso, mayor dificultad en eliminar calor metabólico y falta de consumo de pienso debido tanto a la falta de consumo de agua como a la necesidad de disminuir la producción de calor metabólico.
El consumo de agua está siempre relacionado con el de pienso, siendo la relación agua/pienso de 1,8/1 con bebederos de campana, disminuyendo a 1,6/1 cuando usamos tetinas.
Cuando aumenta la superando la zona de confort, el aumenta el consumo de agua duplicar, incluso a agua/pienso.


Por otro lado, el número adecuado de bebederos de campana pollos. situaría en de 3 kilos mayor de 3 kilos


red

suelo a 0,50-0,80 cm de profundidad, con depósito enterrado y aislado entrada a la nave almacenando el consumo de varios días.

Es imprescindible su instalación cuando usamos la ventilación túnel para evitar que los pollos se desplacen provocando densidades y humedades anómalas (el pollo tiende a colocarse en las zonas más frescas, cerca de la entrada de aire).

Se sitúan cada 30-40 metros, con altura de 50-60 cm y con malla de 5 cm para que deje pasar el aire y debiendo estar colocadas antes de los 14 días de vida.

Parámetro a tener en cuenta, importante en sí mismo. Tomamos en cuenta la densidad medida en kilos/m₂ , no en pollos/m₂.
En condiciones comerciales, una densidad alta reduce de forma considerable la circulación del aire entre los pollos, por lo que la disipación del calor corporal será menor, y, por tanto, la temperatura en su proximidad será más alta al igual que la Humedad relativa (Hr), por lo que el problema será cada vez mayor.

Además, los pollos aumentan su temperatura corporal en mayor grado cuando la densidad es alta (pasarían de 41 ºC a 43-45 ºC lo que podría significar la muerte).
Por tanto, es conveniente planificar y disminuir la densidad de los pollos en épocas calurosas, con la desventaja de que actualmente la época calurosa ocupa más meses que el propio verano.






Lotes más homogéneos
Menos decomisos
Menores índices de consumo
Evita el desarrollo de enfermedades intestinales y reduce riesgos sanitarios
Reduce el consumo de antibióticos




Su sistema de limpieza por rotación facilita la desinfección y contribuye al control de la salmonela Ahorro de tiempo y eficacia en la granja

Ampliar información



De la misma forma, hay que tener en cuenta si la camada en cuestión irá a sacrificio para asadero (1,900 kilos) o para pollo estándar (3,200 kilos), ya que la densidad encontrada en la nave no será la misma (una camada para asadero estará a densidades de 32 kilos/m₂ o más).

1,900 Kg
3,200 Kg
Sin embargo, una crianza destinada a pollo estándar no estará a la edad de asadero a más de 20 kilos/m₂ y la confortabilidad de los pollos y su bienestar tampoco serán los mismos.
Un tema que pasa inadvertido para muchos avicultores es la ventilación a aplicar de noche, cuando se apagan las luces.

Es cierto que de noche baja la temperatura del aire (en el interior de la España peninsular baja entre 10 -15 ºC) y que cada 11 ºC de bajada duplica la Hr (la subida de los mismos 11 ºC la hace caer hasta la mitad), todo eso sin variar el vapor de agua que contiene el aire.
Asimismo, la velocidad de aire que debemos utilizar será diferente, aunque los pollos tengan la misma edad y el mismo peso, pero las necesidades de disipación de los pollos a mayor densidad son mayores, por lo que deberá recibir aire impulsado a mayor velocidad.
Por ello, está desaconsejado el uso de la refrigeración evaporativa, pero es muy importante el mantener la ventilación con aire a la misma velocidad que durante el día.
Sacrificio asadero Pollo estándarEs un tema estudiado en profundidad: los pollos adultos, criados a gran densidad, se tumban, repliegan las alas y las superficies del cuerpo en contacto con el aire son menores, con el aire circulante dificultado por la proximidad de los pollos entre sí, con nulo intercambio en la zona de la pechuga y vientre (que está en contacto con la cama, material aislante) que comienzan a acumular calor, y con la evaporación por jadeo menos efectiva debido a la alta humedad.


Esta situación deriva en un aumento de la temperatura corporal, tanto superficial como profunda, por lo que podemos decir que la temperatura superficial es entre 0,5 y 1,6 ºC más alta que durante las horas de más calor.

Como este hecho es inevitable lo que se debe hacer es limitar que los pollos puedan estar echados mucho tiempo seguido.



El uso de los periodos de oscuridad son un requerimiento legal, pero hay que estar muy pendiente de este tema.
Las 4 + 2 horas legales se pueden convertir (las 2 horas) en 2 periodos de
El uso de la ventilación durante las horas nocturnas es imprescindible, porque lo es el que los pollos puedan descansar durante la noche para cumplir los objetivos de rendimiento, combinado con un uso adecuado de la iluminación.
Además, durante los últimos 3 días antes de la salida podemos bajar el número de horas de oscuridad, incluso eliminarlas, siendo mejor no permanecer en periodo de oscuridad más de 2 horas seguidas.
Por otro lado, siempre que los pronósticos de tiempo anticipen días de pico de temperaturas, se podrían alegar razones de bienestar animal para disminuir el periodo de 4 horas o al menos dividirlo en dos, ya que lo que nos jugamos en este caso no es la mejora de las ratios productivas, sino la propia supervivencia de los animales.


Está demostrado que elevar la temperatura ambiente a 36-38 ºC durante 24 horas a los 5-7 días de vida acondiciona a los pollitos para cuando después de los 30 días, que es cuando más sensibles son al estrés calórico, se presente un pico de calor, reduciendo la mortalidad y el nivel de estrés calórico.

Cuando se prevea una ola de calor o un pico de temperatura puntual, se puede realizar un ayuno de los pollos, desde 3 horas antes del pico hasta 3 horas después, volviendo a alimentar a los pollos una vez que la temperatura haya bajado.

Hay también autores que refieren que la restricción de pienso a un 60% del consumo normal durante los días 4 a 6 de vida reduce la mortalidad cuando aparecen olas de calor a partir de los 30 días.


Serán los nutricionistas de la integración de pollos los que deban realizar los cambios oportunos en el pienso a nivel de:
Es de esperar que en los próximos años en nuestro país las temperaturas medias sean cada vez más altas, con picos de temperatura inmersos en olas de calor de mayor duración y de aparición a lo largo de gran parte del año.
Tipos de pienso
Plan de alimentación
Variación en el perfil de aminoácidos
Relación energía/proteína
Adición de bicarbonato sódico (para luchar contra la alcalosis respiratoria producida)
Vitamina C (para regular la liberación de corticosterona)


Betaína (como osmorregulador intracelular, ante la pérdida de agua y potasio, evitando deshidratación celular y mejorando la absorción de minerales y micronutrientes)
Electrolitos

Etc.
También se puede complementar el perfil nutricional en tiempo caluroso suplementando el agua de bebida (vitaminas y electrolitos) así como la pauta de acidificación apropiada, siempre administrados bajo la prescripción y supervisión de los veterinarios de la integración.

El calor que se produce en el pollo no es de tipo febril, sino metabólico. Es fundamental mantener la homeotermia en el pollo para que exprese todo su potencial genético en la producción de carne.

Los pollos tienen a su disposición mecanismos con los que poder regular su temperatura corporal: físicos (convección, radiación y conducción), químicos (evaporación), de excreción (de líquido y heces), hormonales (disminución de triyodotironina -T3- y aumento de corticosteroides) y de comportamiento (apertura de alas, búsqueda de zonas más frescas).

4 5 6
En pollos ya emplumados de 5-7 semanas la temperatura ambiental que les produce mayor bienestar y maximiza la producción de carne es de 18-21 ºC , con el 50-60 % de Hr. Con estos parámetros ambientales su temperatura corporal profunda es de 40-42 ºC.


A partir de esa temperatura ambiental, el pollo va poniendo en marcha los mecanismos de que dispone, que son suficientes por sí solos para mantener la zona de confort . Ocurre hasta los 25-26 ºC.
Cuando se sobrepasan los 25-26 grados, que es cuando comienza el pollo a disminuir el consumo de pienso y por tanto a disminuir la deposición de músculo, es cuando hay que a ventilar para utilizar la convección. 7 8 9
La ventilación de túnel es el medio más eficaz para mantener a los pollos en la zona de confort térmico.

A partir de los 30-32 ºC y dependiendo de la Hr pondríamos en marcha la refrigeración evaporativa por medio de cooling.

El mejor termómetro es el comportamiento de los pollos al que debemos prestar la máxima atención de forma continuada.
10 11 pollos
La temperatura (y la humedad relativa) no es el único parámetro que decide la velocidad que necesitan los pollos en cada momento. También debemos basar la decisión en otros parámetros, como el grado de emplume, la edad y peso, la densidad y el tipo de pollo al que son destinados en el matadero y su edad de salida.
 Llegó el calor: Una visión actualizada (Parte III) DESCÁRGALO EN PDF
Llegó el calor: Una visión actualizada (Parte III) DESCÁRGALO EN PDF
Los datos del análisis de la embriodiagnosis generan los datos de incubabilidad que nos permiten mejorar la productividad de la planta de incubación, estudiando las fases de mortalidad del embrión y observando si hay oportunidad de mejoría en el proceso como un todo.


Pero en el análisis de la embriodiagnosis, incluso con todas las automatizaciones que existen, aún es un proceso 100% realizado por personas y para eso tenemos que tener personas bien capacitadas para la realización del proceso.

El análisis de embriodiagnosis es el análisis de los huevos no nacidos tras la retirada de los pollitos de la bandeja de eclosión, en el que se contabilizará el porcentaje por fase de mortalidad embrionaria.
La suma de este porcentaje será el resultado de las pérdidas del proceso de incubación.
Cada planta de incubación debe tener una base de datos confiable, para poder establecer sus metas de resultados de eclosión.

Cuanto menor sea la pérdida, mejores serán los resultados.
Podemos enumerar dos parámetros muy importantes para ser monitoreados por los gestores en plantas de incubación, siendo el primero la eclosión total y el segundo la incubabilidad.
1º eclosión total :
Eclosión total es el número de pollitos nacidos dividido por el total de huevos incubados, resultando en el porcentaje de pollitos nacidos.
Pollitos totales
Total de huevos incubados = % eclosión total
Los porcentajes de pérdidas pueden variar entre 5% y 13% según la realidad de cada planta de incubación pues las incubadoras difieren entre sí en diversos puntos, como máquinas (Etapa única X Etapa múltiple), climatización, calidad de huevos o nutrición entre otros.
Para ilustrar mejor vamos a realizar un ejemplo de una incubación de 60.000 huevos donde obtuvimos un nacimiento de 52.500 pollitos, lo que nos resulta en una eclosión total del 87,5%.

52.500/60.000 = 87,5% eclosión total
La eclosión total de manera general se utiliza para la comparación entre lotes, diferentes plantas de incubación y para el cálculo de pollitos por ave alojada.
El porcentaje de nacimiento está influenciado por diversos factores que pueden ocurrir desde la granja hasta la planta de incubación, tales como fertilidad, contaminación, mortalidad inicial, intermediaria y/o final.
El porcentaje de nacimientos nos muestra la eficiencia de la incubación, siendo de esta manera el parámetro más importante para la gestión de la planta de incubación, pues es desconsiderado los huevos infértiles y considerado los datos de mortalidad embrionaria.
La eclosión es el porcentaje de pollitos nacidos dividido por el porcentaje de huevos fértiles.

Realizando el cálculo de incubabilidad considerando la eclosión total obtenida en el ejemplo anterior y con una fertilidad del 97,5%, tenemos una incubabilidad de 89,74 %.
Por tanto, nos lleva a concluir que existe una pérdida de proceso de incubación de 10,26% (diferencia al 100%).
Esta pérdida de proceso debe ser estratificada entre mortalidad inicial, intermedia y tardía, entre otros puntos evaluados en la embriodiagnosis.
% Eclosión total
% Fertilidad = % incubabilidad
52.500/60.000 = 87,5% eclosión total

87,5% / 97,5% = 89,74 % incubabilidad
Ahora vamos a trabajar con un ejemplo práctico, donde vamos a tener 3 plantas de incubación de etapa múltiple (Tabla 1) en la cual podemos observar que la mejor eclosión está en la planta X (85%), pero posee incubabilidad de 87%, o sea una pérdida de incubación del 13%.
Realizando la comparación entre las tres plantas de incubación, la planta X posee la mejor eclosión, pero posee la menor incubabilidad (mayor pérdida de proceso).
En este simple análisis podemos ilustrar la importancia de analizar la incubabilidad, pues la mayor eclosión es la que posee también la mayor oportunidad de mejorar en el proceso.
Este ejemplo nos proporciona afirmar que una buena eclosión puede tener una gran oportunidad de mejora también, ya que la sala Incubación X tiene la mejor eclosión, pero con la mayor pérdida de proceso, o sea una oportunidad de ganancias en proceso.

El análisis de la embriodiagnosis se debe realizar como rutina en la planta de incubación en dos ocasiones:
Este análisis se realiza de forma semanal o quincenal según la programación de cada planta para el análisis de la fertilidad.
Primero se realiza la ovoscopia entre 1014 días de desarrollo embrionario, donde vamos a retirar los huevos claros para evaluación de la fertilidad y mortalidad inicial, tras la identificación de las bandejas que fueron analizadas.
Después de los 21 días, retirar los pollitos y realizar el análisis de los huevos sin eclosionar para evaluar la fase de mortalidad.
Proporciona datos más precisos sobre la fertilidad y la mortalidad temprana del embrión.
Permite un mejor análisis entre los huevos infértiles y la mortalidad inicial debido a la menor descomposición de los huevos debido al calor y al tiempo de incubación.

Permite observar la posición en que los huevos han sido incubados (cámara de aire arriba o abajo).
Programación para realizar la prueba, tiene conocimiento de los días de acción de la muestra.
Algunos cuidados para la correcta evaluación de la fertilidad + embriodiagnosis:
Identificar la bandeja realizada con la muestra para que no haya intercambio de la muestra en la transferencia de los huevos a las cajas de eclosión.

Entrenamiento del equipo de transferencia para marcar correctamente las cajas de prueba.

2º Análisis embriodiagnosis para investigación de la caída de eclosión.
Cuando hay caída en la eclosión programada del lote es necesario realizar una ruptura del análisis de la embriodiagnosis para intentar observar la causa de la caída del resultado evaluando las fases de desarrollo embrionario.
Vamos a realizar la rotura de residuo después de los 21 días, retirando los pollitos nacidos y analizando los huevos no eclosionados de las muestras.

Algunos cuidados para la asertividad de la evaluación de la embriodiagnosis para la investigación de la caída de eclosión:
Ideal tomar la muestra por nacedora y lote. Además, permite realizar un análisis por separado para una mejor comparación entre los resultados.

Tomar muestras de cajas de diferentes puntos de la nacedora.

Mejores resultados cuanto mayor sean las muestras. Ideal es tener un mínimo de 6 bandejas por nacedora.

Mayor atención a la descomposición para no confundir infértiles y mortalidad temprana.
De modo resumido, las categorías son:
Infértiles
Fotografía 1. Cajas marcadas. Fotografía 2. Huevo infértil. Fotografía 3. Muerte inicial.




Todos los equipos automatizados para plantas de incubación
Miraje, Vacunación INOVO Technolog ía

Soluciones para incubadoras grandes, medianas y pequeñas
Construcción de acero inoxidable fuerte y resistente
Nuevas tecnologías de proceso de OAC que evitan las micro fisuras y la contaminación y mejoran el porcentaje del nacimiento
INOVOVAC con tecnología V.I.S.A
Detección sin contacto de huevos volcados y rotos
TECNOLOGÍAS AVANZADAS Y INNOVADORAS


Reduce la contaminación y mejora la Eclosabilidad
NECTRA LIFE CANDLING: Detecta embriones vivos y muertos dentro del huevo.
ACUTE DETECCIÓN AL REVÉS: Detección sin contacto de huevos al revés y sin rodar los huevos. Mejora de la incubabilidad entre un 1 y 2 %
SMART Tecnología de llenado ordenado OAC directamente en bandejas de incubación, evita rodamientos y golpes en las cintas : Previene las fisuras de los huevos así como la contaminación debido a la fricción en la cinta transportadora, y mejora el porcentaje del nacimiento

OVOSEX1 : sexado no invasivo en el huevos fertil (ponedora)
Encuéntrenos en el stand N°C65 del 12-14 Septiembre en SPACE


Tecnología NECTRASCAN Y NECTRALIFE


Muy alta precisión, identifica embriones
Desapilador de la bandeja incubacíon
Carrusel de vacunación y vacunación lineal
Transferencia de huevos



Máquina contar de pollitos láser de alta precisión






Separador de cáscara de pollito
ACUTE : detección sin contacto de huevos al revés y detección de los huevos fisurados sin rodar

Dentro de la mortalidad final podemos tener divisiones como:
Pollitos picados
Mala posición
Contaminados (bacteriano

Invertidos

Fisurado de transferencia

Anomalías etc.
Hay varias maneras de dividir las categorías de mortalidad embrionaria, desde más simples hasta más específicas.
A continuación, observamos un ejemplo muy utilizado como un medio de análisis, ya que tiene los principales puntos para ser analizados y, así, mejorar la toma de decisiones.
Fotografía 4. Muerte intermedia. Fotografía 5. Muerte final. Tabla 2. Método de análisis para análisis de la mortalidad embrionaria.


Uniformidad de las muestras realizadas. Estandarizar el número de bandejas analizadas.
Test de fertilidad y embriodiagnóstico. El ideal es realizar siempre la muestra por aviarios de producción y haber anotado la fecha de producción para mejor cálculo de los días de almacenamiento.

Estandarizar la periodicidad de los análisis de fertilidad (semanal, quincenal, mensual). Cuanto menor sea el período entre los análisis, mejor será la curva de los datos.
Mantener siempre, en incubadoras con vacunación in-ovo o que retiran huevos claros en la transferencia, una muestra de bandejas sin retirar los huevos y marcarlas para que en la selección de los pollitos sean separadas para romper el residuo en caso de caída en la eclosión programada.

Tener una programación de reciclaje de entrenamientos teórico – prácticos para evaluación de rotura de residuo.
Es muy importante una programación anual o semestral, según la necesidad de cada planta, para reorientar a los empleados para sacar dudas, ya que este es un proceso 100% dependiente de personas y estos resultados forman parte de la toma de decisiones.


Mortalidad inicial (0 a 7 días):
Tiempo de almacenamiento. almacenamiento la capacidad de incubación disminuye de 0,5% a 1 % por día de almacenamiento.
Temperaturas:
Permanencia del huevo en el nido a temperaturas altas en tiempo prolongado
Cambios bruscos de temperatura, para frío y para calor
Temperatura de transporte de los huevos
Temperatura de almacenamiento sala de huevos

Desinfección
Precalentamiento inadecuado

Condensación en los huevos
Cambio en la incubadora
Problemas de sanidad
Problemas nutricionales
Mortalidadintermedia(8-14días):


Problemas de volteo
Ventilación en la incubadora
Temperatura muy baja/alta
Nutrición
Problemas de sanidad
Problema de humedad final de la incubación y/o nacedora (humedad muy baja o muy alta)
Temperatura incubadora/nacedora
Tiempo de inventario muy alto
Problemas de volteo en la incubadora
Ventilación en incubación y nacedoras
Pérdida de mucha temperatura al transferir los huevos
Contaminación
Vacunación in-ovo (cuando el embrión ya está muy adelantado)
Mala posición o invertido
Pollitos picados
Horas de incubación
Ventana de nacimiento
Trauma durante la transferencia

Pérdida de temperatura durante la transferencia
Temperatura de nacedora
Fumigación excesiva
Análisis de los resultados:
En el análisis de resultados vamos a tener resultados dentro del patrón y otros fuera. Para los resultados fuera del estándar tenemos que hacer algunas preguntas:


¿Esto es recurrente o puntual?
¿Está sucediendo en más de un lote de reproductoras?
¿Cuál fue la fase más desvío?
¿Se vieron afectados los resultados de la eclosión?
¿La calidad de los pollitos se vio afectada?
En los resultados podemos tener más de un factor fuera del estándar, por lo que para iniciar la investigación es importante hacer una lista con posibles causas para cada fase.
Desde Agrener hemos tenido el compromiso de proveer y montar instalaciones de placas fotovoltaicas para ayudar a nuestros clientes a amortiguar el aumento de costes de producción en toda la cadena



TRABAJAMOS CON LAS MEJORES MARCAS DEL SECTOR
GRANJAS

MATADEROS
FABRICAS DE PIENSO
SALAS DE INCUBACIÓN
Caída en la eclosión de un lote en 3% (siendo observado 25% de los pollitos atrasados).

En el análisis de la embriodiagnosis fue observado un aumento en la mortalidad inicial, del porcentaje de pollitos recién nacidos en las cajas.
Días de almacenamiento de huevos
Oscilación en la temperatura
Desinfección de los huevos
Precalentamiento inadecuado (tiempo o temperatura)
Condensación de los huevos
Temperatura de incubación
Volteo en la incubadora Pollitos atrasados
Días de almacenamiento de huevos
Oscilación en la temperatura
Precalentamiento inadecuado (tiempo o temperatura)
Ventilación nacedora
Temperatura incubadora/ nacedora
Tempo de transferencia
Tenemos 3 hipótesis en común para los problemas (ítems subrayados). Después de estudiarlas e iniciar una investigación inversa para verificarlas, son:
Análisis de la ficha de precalentamiento para ver cómo fue la temperatura de precalentamiento
Análisis de los días de inventario de los huevos incubados, estudios de las horas de incubación
Análisis de la temperatura de granja, transporte y sala de huevos.
El problema de estudio de la causa fue la falta de incremento de horas de incubación.
Había huevos con 4 a 7 días de incubación y un pequeño número de huevos con 9 días de almacenamiento.
Cuando el almacenamiento de huevos sube de 6 días, deben ser añadidas horas de incubación para cada día más de almacenamiento.

Cuando no ocurre este incremento de horas, hay un retraso en el nacimiento de los pollitos.
Los altos días de almacenamiento también dejan las células embrionarias más frágiles promoviendo un aumento de mortalidad embrionaria inicial.
Después de estudiar las causas tenemos mejor condición de llegar a un diagnóstico y a una toma de decisión.
La importancia del análisis de los datos de embriodiagnosis para la gestión de la planta de incubación
DESCÁRGALO EN PDF

Todas las versiones del Bolegg Gallery (de uno, dos o tres pisos) incorporan cintas para huevos en todos los niveles permitiendo una recogida fácil. Un mecanismo de cierre del suelo del nido evita la contaminación del nido por la noche y permite retirar el polvo y la suciedad con facilidad cuando se cierra el nido. El sistema Bolegg Gallery ofrece un medio ambiente higiénico mediante la combinación del nido y el suelo de malla metálica. Además, los suelos de los distintos niveles cuentan con una cierta inclinación para conseguir recoger los huevos puestos fuera del nido.

El Bolegg Gallery aprovecha el espacio vertical para aumentar el número de aves en la superficie utilizada. Su estructura abierta facilita la inspección; las paredes posteriores elevables permiten la inspección del nido; y, su diseño en árbol ofrece una visión general y acceso a todos los niveles. Este diseño, combinado con su fácil funcionamiento, facilita la gestión de todo el sistema de aviario.
Vencomatic Ibérica S.L.
T. : 977 331 908 | E: info@vencomatic.es
C/ Pintor Fuster, 21 | 43205 REUS (Tarragona) Agustin Martin

Para más información Bolegg Gallery
www.vencomaticgroup.com
 Aitor Larrabe Costillas
Sales Manager 660 731 629
Aitor Larrabe Costillas
Sales Manager 660 731 629
 Bolegg Gallery
Bolegg Gallery
Equipo Técnico Vencomatic Ibérica
En Vizcaya encontramos la granja de la familia Larrabe con más de 60 años de experiencia en el sector avícola.
Avícola Larrabe ha logrado consolidarse como una de las más grandes del País Vasco con una producción de algo más de 200.000 huevos diarios.

Actualmente, gestiona la granja la segunda generación de granjeros de la familia, siendo 4 socios actualmente.
Forman parte de la cooperativa OVO 12, cuyo objetivo es mejorar la calidad y la competitividad en un mercado cada vez más exigente.
Con un total de 7 naves, con distintas capacidades que oscilan entre las 40.000 y las 50.000 por nave, suman un total de unas 260.000 gallinas.

De estas 7 naves, dos aún son de gallinas en jaula y 4 están equipadas con sistemas de aviario libres de jaula.
La séptima nave actualmente se encuentra en proceso de montaje y también contará con sistemas libres de jaula.

La última nave destaca por sus dimensiones de 80 metros de largo por unos 15 metros de ancho, tamaño similar a las otras naves, aunque todas tienen medidas distintas.

En este caso, la nave dispone de dos plantas, y al haber optado por instalar sistemas Bolegg Gallery de 3 pisos se consigue una superficie total mucho mayor que permitirá albergar a una cantidad de 46.000 gallinas en la nave.
En 2016 aprovecharon la creciente tendencia hacia los sistemas libres de jaula para reconvertir sus sistemas de alojamiento para empezar a eliminar gradualmente las jaulas de sus naves.
Empezando con tan solo una de las naves para poder poner a prueba el modelo de aviario.
El funcionamiento de los sistemas les gustó y los resultados fueron mejores de lo esperado, por lo que decidieron seguir con la reconversión de sus naves durante los años siguientes hasta el día de hoy, en el que la mayoría de sus naves ya son libres de jaula.
Conscientes de su falta de experiencia previa en sistemas de aviario, confiaron en Vencomatic sabiendo que la empresa ya tenía una amplia experiencia previa en la avicultura sin jaulas.

La empresa instaladora les transmitió la confianza suficiente para dar el paso y adentrarse en este nuevo modelo de avicultura sin jaulas.


El sistema elegido para todas las naves libres de jaulas siempre ha sido el Bolegg Gallery de 3 pisos, gracias a los buenos resultados obtenidos con anterioridad.
Además, optaron por el Bolegg Gallery debido a las características y ventajas que presentaba.
Entre ellas, la posibilidad de encerrar a las gallinas dentro del sistema les daba cierta tranquilidad, aunque, tal como nos reconoce Kepa, nunca les ha sido necesario.
De la misma manera, los suelos de malla de acero del Bolegg Gallery cuentan con una ligera inclinación que permite que en caso de haber huevos fuera del nido puedan llegar rodando hasta el nidal y sean recogidos por las cintas.
La cantidad de huevos en el suelo siempre es una de las preocupaciones más comunes en una granja y esta no fue la excepción. Al pasar de un sistema con jaula a uno donde todas las gallinas se mueven libremente por toda la superficie del aviario, la cantidad de huevos fuera de los nidos puede llegar a suponer un problema.
Figura 1 y 2. Planificación nave Avícola Larrabe por Vencomatic GroupEn Avícola Larrabe tienen tan solo un 0,1% de huevos en el suelo, gracias a el buen diseño del sistema que recoge los huevos puestos en las plataformas y a una buena adaptación de las aves al tipo de sistema
Esto nos permitirá mejorar la producción y minimizar la cantidad de huevos en el suelo.
“Al principio, cuando entran las gallinas hay que tener mucho cuidado de acostarlas bien por las noches y estar muy encima de ellas hasta que se amoldan al sistema, pero bueno, al final los resultados han sido buenos, vamos, mejor de lo esperado” – Kepa Larrabe
Las pollitas entran al sistema cuando tienen unas 16 semanas de vida, lo que les permite adaptarse a su entorno, sobre todo cuando estas pollitas han sido criadas teniendo en cuenta las capacidades necesarias para moverse en un sistema de aviario libre de jaulas.

Las gallinas permanecerán en la granja durante los siguientes 14 meses, por lo que abandonarán la granja al llegar a los 18 meses de vida.
El sistema Bolegg Gallery ha sido diseñado con el objetivo de facilitar al máximo la labor del granjero.
El sistema se basa en un diseño con concepto de árbol que permite una inspección sencilla de los distintos niveles.

Las perchas colocadas estratégicamente a lo largo de todo el sistema permite que las gallinas se muevan libremente por los distintos niveles sin obstáculos.

Aseladero Ponedero
Cinta de estiércol LED Separación de malla de alambre
El sistema cuenta con nidos en 2 niveles del aviario y de una cinta para la recogida de huevos en el tercer nivel.
Los nidos están capacitados para albergar gran cantidad de gallinas, así como para poder inspeccionarlos fácilmente gracias a que la pared trasera se puede levantar.
Además, se aseguran de que los nidos se mantengan limpios mediante el sistema de cierre automático durante las noches.
 Fotografía 2. Interior Bolegg Gallery
Figura 3. Funcionamento interior Bolegg Gallery
Fotografía 2. Interior Bolegg Gallery
Figura 3. Funcionamento interior Bolegg Gallery
En cada uno de los 3 pisos del Bolegg Gallery se encuentran líneas de comedero y bebederos suficientes para que todas las aves puedan acceder fácilmente a comida y bebida en todo el sistema.

La extracción de residuos se lleva a cabo mediante cintas en los tres niveles que transfieren la gallinaza a la cinta transversal Hercules que se encarga de extraer los desechos fuera de la nave de forma fácil y segura sin necesidad de un foso.
“Como nosotros tenemos un sistema de compostaje en la granja y toda la gallinaza que se produce se composta, normalmente sacamos lo que es la gallinaza cada 2 días. Optamos por el sistema Hercules, antes teníamos las típicas cintas que van metidas en un foso y claro los fosos son un agujero negro, por mucho que intentes limpiarlo y demás es complicado y pues con la Hercules eso no sucede, vamos, de hecho, en naves que teníamos con foso optamos por tapar el foso y colocar el sistema de cinta Hercules”

La gestión de la gallinaza siempre ha sido una preocupación en Larrabe.

“Ya nuestro padre decía que había que hacer algo, no le convencía que tuviera que venir un camión todos los días a sacarla de la granja, y nosotros estábamos de acuerdo”. Había que buscar alguna manera de valorizarla.
Valoraron diferentes soluciones, pero ninguna les convencía del todo, hasta que apareció Smart Compo, con la tecnología de compostaje COMPO de origen japonés.
Larrabe buscaba una solución que no requiriese mucha mano de obra, que fuera sencilla de operar y con poco mantenimiento.
También les preocupaba mucho el tema medioambiental, por lo que querían una planta que les permitiera cumplir la normativa actual y la futura.
La tecnología COMPO cumplía con todos esos requerimientos y les gustó su formato compacto y cerrado.
Por lo tanto, fueron a visitar una instalación en funcionamiento y en el 2018 montaron la primera máquina.
 Fotografía 3. Gallinas ponedoras en Bolegg Gallery
Fotografía 4. Cinta transversal Hércules
Fotografía 3. Gallinas ponedoras en Bolegg Gallery
Fotografía 4. Cinta transversal Hércules
Ésta les permitió valorizar el 50% de la gallinaza generada en la explotación, alrededor del 20% más de lo previsto inicialmente, así que estaban muy contentos.
“La máquina es muy sencilla de manejar, la carga y descarga no nos lleva más de hora y media al día y no tuvimos problemas para conseguir las autorizaciones pertinentes”.
Con la primera máquina participaron en un Proyecto En Cooperación de Economía Circular, colaborando con un Centro Tecnológico y una Cooperativa Agrícola, entre otros.


Los resultados fueron muy positivos.
Actualmente, Avícola Larrabe cuenta con dos equipos y trata la totalidad del residuo generado: la gallinaza y los huevos rotos.
Además, gracias a la programación y optimización de los equipos, también les permitirá procesar la gallinaza generada en la nueva nave que están construyendo.

El producto obtenido del compostaje está inscrito como fertilizante orgánico NPK y su venta les permite obtener un ingreso extra para la granja.
De momento, han cumplido su objetivo y, aunque su prioridad sigue siendo la producción del huevo fresco, no descartan avanzar en la producción del fertilizante, ya sea dándole un formato de pellet o gránulo o enriqueciendo la fórmula.


En Larrabe ya han dado el paso hacía la avicultura libre de jaulas y con una visión más sostenible.
El consejo que trasladan para cualquier granjero que esté pensando en eliminar las jaulas y dar el paso a sistemas de aviario es el siguiente:
“En aviario no es igual que en las jaulas. Al estar las gallinas ahí metidas no hay ningún problema, pero en aviario siempre hay cosillas. Por ese motivo, hay que optar siempre por un aviario que ya tenga cierto recorrido, vamos, que no sea un invento nuevo porque los inventos en las gallinas de suelo no suelen ser muy buenos, tiene que ser algo muy probado.”
Fotografía 5 y 6. Generación de compostaje gracias a Smart Compo“El que compra nuestro fertilizante, repite.”Avícola Larrabe apuesta nuevamente por el sistema Bolegg Gallery DESCÁRGALO EN PDF

En la industria avícola se utilizan muchos tipos de fuentes de luz, desde naves abiertas bajo la influencia del sol hasta las naves con la tecnología más avanzada con el equipo más nuevo sin la influencia de la luz exterior.
Es importante entender la composición espectral de las diferentes fuentes de luz para seleccionar entre los múltiples tipos de luz.
 Equipo Técnico Hy Line
Equipo Técnico Hy Line
Proporcionan un espectro total de luz.
Típicamente son las bombillas de luz más eficientes medidas en lúmenes por vatios.
Debido a que las luces LED emiten radiación infrarroja (calor), pueden ser hechas de materiales que no son de vidrio y son impermeables.
Comúnmente están fabricadas con materiales que no son tóxicos.

Pueden ser diseñadas para enfocar la luz en las áreas deseadas.
El espectro del color de la luz puede ser ajustado dependiendo del fósforo utilizado.

Son más fáciles de atenuar que las bombillas de luz fluorescente compacta.
La atenuación puede extender la duración de vida de la bombilla.
Tienen una larga vida – de hasta 10 años a 16 horas por día (50.000 – 60.000 horas).
Alcanzan rápidamente el pico de intensidad de la luz después de encenderlas.
Ideales en las áreas donde la luz se enciende y se apaga frecuentemente.
Eficientes en clima frío sin cambios en el rendimiento.
Son más caras
Se debe utilizar un control apropiado para disminuir la luz, de otra manera la bombilla parpadea y se funde más rápido.
La luz LED es direccional y requiere de una lente apropiada para enfocar la luz o de difusores adecuados para cubrir un área más amplia.
Puede ser necesario cambiar el cableado eléctrico en una nave ya existente para poder cumplir con las especificaciones de las luces LED.
La eficiencia de los filamentos de calor se reduce con la acumulación de polvo, mala ventilación alrededor de la bombilla o al ponerla en un “frasco” para protegerlos contra el agua.
Puede que las luces no se fundan después de la vida útil esperada, pero la luz será 70% más tenue del flujo luminoso inicial. Como resultado, es necesario hacer pruebas básicas de lux en la nave para determinar cuando deben cambiarse las bombillas.
Las luces LED más baratas pueden no tener el calor, espectro o garantías adecuadas para utilizarse en un ambiente avícola.

El primer y único postbiótico de AO para gallinas ponedoras, utilizando tecnología pendiente de patente.
Obtén más huevos comercializables, más masa de huevo y extiende la vida productiva de las gallinas con AO-Biotics EQE. Basado en los 70 años de experiencia de BioZyme en fermentación con Aspergillus oryzae (AO) para ofrecer productos que mejoran la salud, el bienestar y la productividad de los animales. Expertos en AO. El Menos Común de Todos.

Donde la atención es un círculo completo. BioZymeInc.com


La luz emitida por una bombilla LED es direccional inherentemente y puede crear sombras cuando hay poca difusión del lente o dependiendo del lugar donde se coloca en la nave.
Mientras se logre una salida del ángulo de luz de menos de 180°, puede ser beneficioso dirigir la luz hacia las aves, ya que el espacio entre las luces debe ser adecuado para evitar sombras. Las luces que cuelgan demasiado bajo o con un ángulo de menos de 120° producen un efecto de “enfoque en relieve,” creando conos con áreas de luz y de oscuridad en la nave.
Aunque estas luces pueden utilizarse eficazmente, el enfoque en relieve debe ser minimizado colocando y separando las luces cuidadosamente.
La distribución de la luz dispareja es un problema en sistemas de alojamientos en piso y en jaulas.
En las naves con aves en piso, la distribución de la luz dispareja causa sombras, creando áreas para que las aves aniden, resultando en un mayor número de huevos puestos en el piso.

En los sistemas con jaulas o con colonias, la distribución de la luz dispareja, puede causar que algunas jaulas tengan demasiada luz y otras muy poca, lo cual lleva a que unas aves tengan demasiada estimulación y otras tengan poca estimulación dentro de la misma nave.
Las luces LED no emiten tanto calor como las luces incandescentes o fluorescentes.
Por lo tanto, se pueden utilizar materiales de plástico o de policarbonato para las lentes y difusores.
Mientras que las nuevas generaciones de luces LED tienen mejor difusión de luz, todavía es importante entender la salida direccional de la luz de las bombillas LED y la planificación de su sistema de iluminación, teniendo en cuenta:

La ubicación.
La intensidad de la luz.
El uso previsto.
La mayoría de los fabricantes de luces LED tienen programas de computación que valoran la distancia, la altura y la salida de lumen requeridos para iluminar adecuadamente cualquier instalación.
Aunque el uso de la cromaticidad (K) puede ayudar a separar las diferentes luces con una luminosidad similar, esta medida no toma en cuenta con precisión la calidad espectral completa de la luz.

Las luces LED pueden requerir de un cableado eléctrico diferente en un alojamiento.
En este sentido, algunos países prohíben el uso de enchufes tipo rosca que no son a prueba de agua y, en su lugar, requieren que las luces se conecten directamente a las cajas de conexiones.

Hay que verificar los reglamentos locales antes de instalar o de adaptar una nave para el uso de las luces LED.


Los controles para atenuar la luz deben ser compatibles específicamente con las luces LED instaladas y usarse con bombillas LED clasificadas para atenuarse. Los controles incompatibles para atenuar la luz pueden causar que las luces parpadeen, se sobrecalienten o se fundan con mayor rapidez.
Las luces LED no tienen un filamento resistente, como los de las bombillas incandescentes, y requieren de atenuadores para manejar el complejo de carga eléctrica para controlar la salida de potencia de voltaje.
Una luz LED con buena capacidad reguladora requiere del equipo adecuado para atenuar aún teniendo un regulador apropiado para LED.
No todas las luces LED están diseñadas con capacidad para ser atenuadas y no todas las luces LED con capacidad reguladora trabajan exactamente según lo previsto.
Una luz LED con un buen regulador tendrá una resistencia integrada en el regulador para garantizar un rendimiento consistente al atenuar la luz.
Las luces LED mantienen la eficiencia cuando se atenúan y pueden extender la vida de la bombilla.
Trabaje con un fabricante de luces LED para asegurarse de instalar el regulador correcto.
Los reguladores para atenuar las luces incandescentes y las luces LED operan de una manera similar. Sin embargo, los reguladores LED deben tener mayor control en la salida de la potencia del voltaje.
Un regulador prendido a 50% fluctúa entre, aproximadamente, 3 watts.
Puede ser difícil seleccionar la bombilla de luz LED adecuada una vez que se ha tomado la decisión de construir o modernizar una nave. Hay tres clases de bombillas de luz LED disponibles actualmente:

Las luces LED más costosas para utilizarse específicamente en avicultura están diseñadas para la visión de las aves y sus fabricantes entienden las necesidades de la industria avícola. Estas luces generalmente están clasificadas para soportar los procedimientos de limpieza y desinfección en una nave.


Una bombilla de luz incandescente de 60-watts subirá en uso de energía de 27 a 33 watts, lo cual no puede ser detectado por el ojo humano.
El mismo regulador en una bombilla de luz LED fluctuando a 10-watts causará una diferencia de uso de energía que subirá de 2 a 8 watts.
Este cambio extremo en la energía que va a la luz causará un parpadeo notable. Adicionalmente, aun las fluctuaciones menores en poder de energía pueden causar que una luz LED atenuada parpadee.
Las luces LED generales clasificadas para la agricultura, generalmente pueden soportar las condiciones del medio ambiente en una nave.
Aunque estas luces son menos caras, es importante comprender todos los detalles (incluyendo la salida de luz, espectro, garantía y nivel de impermeabilidad) antes de instalarlas.
Las luces LED estándares para uso doméstico instaladas en naves han tenido muchos de los mismos problemas que las luces especiales para la agricultura.
Estas luces generalmente no están fabricadas para utilizarse durante 16 horas diarias, lo que lleva a mayores niveles de disminución de la luz o a que las luces se fundan prematuramente debido al calor o circuitos inadecuados.
En general, los diferentes tipos de bombillas de luz LED tienen usos ideales:
Las luces muy direccionales (30–50°) colocadas muy cerca del centro (1.8 a 2.4 m) pueden proporcionar una iluminación uniforme en las naves con jaulas altas.
Las luces extensas a (> 180°) son más eficaces para alojamientos en piso.
Las luces con direccionalidad media (90–150°) pueden utilizarse en una variedad de ambientes, dependiendo de la separación y del flujo luminoso.
La duración, el espectro, y la intensidad de la luz son muy importantes para obtener picos óptimos y mantener la producción de huevo.
Aunque hay muchas opciones de iluminación disponibles para los productores avícolas, las luces LED son cada vez más populares debido a que cuentan con una combinación de energía eficiente, fiabilidad y larga vida.
Mientras aumenta el uso de las luces LED, la comprensión de la aplicación apropiada en varios tipos de sistemas de alojamiento va a aumentar.
Entendiendo La Luz en Avicultura DESCÁRGALO EN PDF
Se espera que en el futuro las luces LED bajen de precio, mejorando su eficiencia y aplicación.
GREEN WAY 30 MAX para PONEDORAS
GREEN START para CRÍA-RECRÍA

VISION para PONEDORAS
VISION ASIMÉTRICO para PONEDORAS
GREEN WAY 30 para PONEDORAS
VISION SURFACE para PONEDORAS
GREEN WAY 24
MAX para PONEDORAS
VISION LARGE SURFACE para PONEDORAS
GREEN WAY 24 para PONEDORAS
La coccidiosis aviar, enfermedad causada por parásitos intestinales del género Eimeria (en pollos principalmente E. acervulina, E. maxima es reconocida como una de las enfermedades más costosas para la industria avícola a nivel mundial 3 millones de dólares anuales -
Se trata de una enfermedad que cursa de modo clínico y subclínico, afectando a la integridad intestinal y, por ende, generando inflamación y pérdidas en los parámetros productivos por falta de una correcta absorción de los nutrientes y los costes metabólicos asociados a la infección y a la respuesta inmune del ave.
 Equipo técnico de Zoetis
Equipo técnico de Zoetis
Las herramientas para el control son limitadas (coccidiostáticos químicos, ionóforos y vacunas) y de ahí la importancia capital de:
Una buena estrategia rotacional planificando el uso de los diferentes productos considerando sus tiempos de actuación eficaces.
Los mecanismos de acción y los períodos de descanso que se precisan para maximizar su efectividad y la resensibilización de las Eimerias.
Hace muchas décadas que los coccidiostatos vienen siendo la principal herramienta para el control efectivo de la coccidiosis en la avicultura industrial.

Se clasifican en dos grupos:
Sintéticos (comúnmente llamados Químicos).
Ionóforos (obtenidos a partir de la fermentación fúngica).
De esta manera, evitaremos la aparición de resistencias que favorezcan brotes agudos o efectos subclínicos, siendo estos últimos los de mayor repercusión económica en la integración.
La utilización estratégica de estas herramientas con mecanismos de actuación diferentes sobre los ooquistes, es una parte muy importante del éxito en los resultados y es la base para la confección de un programa de control de coccidiosis.
Esta estrategia rotacional debe basarse en criterios estrictamente científicos, aprovechando las ventajas de los distintos productos según cada momento y valorando las condiciones individuales de cada integradora.
Debemos considerar los distintos mecanismos de acción de las diversas moléculas y la evidencia científica que los soporta a la hora de establecer un uso rotacional, para así asegurar su máxima eficacia en cada situación.
No utilizar el mismo anticoccidiósico de manera continuada durante mucho tiempo
Ionóforos: máximo 6 meses
Sintéticos: en full máximo 3 meses y en shuttle máximo 4,5 meses
Permitir a las moléculas el descanso suficiente
Ionóforos: mínimo 6 meses (dentro de la misma clase de ionóforo)
Grupo Compuesto Modo de acción* Sitio de acción
Monovalente
Monesina
Narasina
Salinomicina
Monovalentes glicósidos Maduramicina Semduramicina*
Divalentes Lasalocid
Ionóforos Sintéticos o químicos:

Transporte de iones monovalentes (Na+, k+)
Transporte de iones monovalentes y divalentes (Na+, K+, Ca++, Mg++)
Membrana plasmática
El uso continuado de moléculas anticoccidiales puede llevar a la aparición de resistencias (reducción de la sensibilidad del parásito a un fármaco específico). Podríamos catalogar a las resistencias en tres tipos (WHO scientific Group, 1965):
Adquirida, por reducción heredable de sensibilidad de ciertas cepas a moléculas tras su uso continuado.
Cruzada , por intercambio de resistencia entre moléculas con idéntico modo de acción.
Múltiple, por resistencia a más de una droga a pesar de tener diferentes modos de acción.
Estudios realizados a finales de la década de los 70 (Weppelman y col., 1977), mostraron una correlación positiva en resistencias y sensibilidad entre ionóforos del mismo grupo monovalente (monensina, salinomicina y narasina) y correlación negativa entre el único ionóforo divalente (Lasalocid) con respecto a los ionóforos monovalentes.
Compuesto Modo de acción*
Nicarbacina Se cree que actúa inhibiendo la formación de bases púricas y pirimidínicas a nivel cromosómico
Robenidina Se cree que inhibe la fosforilación ocidativa en la mitocondria

Diclazuril Afecta el metabolismo respiratorio
Decoquinato Bloqueo del transporte de electrones inhibiendo la respiración
Halofuginona Desconocido
Amprolio Antagonista tiamina
* En algunos casos no está completamente claro
Estas correlaciones se explican según las actividades bioquímicas que utilizan.
Los ionóforos forman complejos liposolubles con cationes (K+, Na+, Ca++ y Mg++ son los más importantes biológicamente) que les capacita para transportarlos a través de la membrana celular del parásito, pero difieren en la selección de dichos iones.
Este mecanismo de transporte de cationes a través de la membrana rompe el equilibrio iónico celular de las Eimerias, obligando a un consumo excesivo de energía que limita
Además, provoca un aumento de la cantidad de líquido en el interior de la célula hasta llegar a la “explosión” de su estructura muerte del parásito.
Tabla 1. Mecanismos de acción de ionóforos.INÓFOROS MONOVALENTES INÓFOROS DIVALENTE
Este mecanismo diferencial del Lasalocid podría explicar la mínima incidencia que tiene en el consumo de agua a diferencia de los monovalentes; que como en ocasiones se reporta (Radu y col., 1986; Wheelhouse y col., 1985b; B. L. DAMRON, 1994), sí generan descensos en dicho consumo.
Este punto adquiere una importancia relevante en épocas de calor ya que, si los animales ingieren menos agua , repercute también en menor consumo de pienso y, por tanto, en los resultados productivos.


Por tanto, la utilización de ionóforos divalentes en periodos de más calor podría ayudarnos a mantener mejores consumos, pesos y conversiones.
Los ionóforos monovalentes (Narasina, Salinomicina y Monensina) actúan sobre los mismos iones monovalentes como Na+ y K+ (Burg, 1976 y Mitani y col.,1975)
Por otro lado, los ionóforos divalentes (Lasalocid), como modo diferencial, son capaces de transportar iones divalentes como Mg++ y Ca++ adicionalmente a los iones monovalentes (Pressman, 1968 y 1973).
Esta actividad adicional podría ser la responsable de la habilidad frente a cepas de coccidia no controlables por los monovalentes al tener una sensibilidad reducida (Weppelman y col., 1977)
Monensina Salinomicina Narasina Lasalocid patología
Son altamente efectivos y excelentes herramientas para programas de limpieza o previo a la aplicación de las vacunas, pues facilitan la implantación con la mínima competencia de cepas de campo patógenas y agresivas.
de distinta clase.
Un error típico es creer que se está realizando una rotación entre ionóforos de una misma clase en lugar de realizarla con ionóforos
Se han establecido como una herramienta de rotación más junto a los coccidiostáticos.
Las vacunas autorizadas en Europa son atenuadas a diferencia de EEUU.
Es importante la buena aplicación, condiciones de humedad y control para evitar problemas en la replicación con la consiguiente falta de inmunización.
Así como preparar la entrada a rotación con vacuna , con la menor población de ooquistes patógenos para facilitar la dispersión rápida de la vacuna.
Deben ser aplicadas con rigurosidad y con las condiciones adecuadas en las granjas para asegurar que cumplan los ciclos necesarios.
De esta forma, se generará una adecuada respuesta inmune y alcanzará todo su potencial.
Estudiar la situación, valorar los resultados y planificar adecuadamente es CLAVE para mantener una estabilidad en el control de esta costosa enfermedad a largo plazo.
Diseñar las rotaciones alternando productos con mecanismos de acción diferentes nos llevará a evitar resistencias cruzadas, permitiendo:
Expresar su máximo potencial genético en consecuencia de una excelente salud intestinal.
Mejorar el nivel de bienestar animal.
Maximizar los resultados económicos.
Salinomicina
Monensina
Narasina
Rotar siempre entre las diferentes clases de inóforos
Lasalocid
Maduramicina
Semduramicina
Las herramientas son limitadas y deben ser utilizadas estratégicamente en base a la evidencia científica.

La coccidiosis es una enfermedad de alto coste, tanto en su forma clínica como subclínica.

Cada periodo de rotación es clave para el resultado óptimo y sostenible a largo plazo.
La rotación con ionóforos debe realizarse alternando los monovalentes y divalentes para evitar la aparición de resistencias.
Usar un anticoccidiósico químico por lo menos una vez al año para realizar una reducción drástica de coccidios en campo o previo a la vacunación para ayudar a su correcta implantación.
Idealmente, planificar estrategias y opciones de uso de productos a largo plazo (mínimo 2 años vista) para obtener resultados exitosos y maximizar el potencial genético del ave.
Para ello, una limpieza previa con un químico altamente eficaz es una práctica habitual y recomendable.
Muchos factores se deben tener en cuenta a la hora de planificar un programa de control estratégico frente a la coccidiosis: estado sanitario, condiciones ambientales, costes, rotaciones previas, etc.
Con una amplia experiencia, conocimiento científico y espíritu de colaboración, Zoetis puede ayudarte a construir la estrategia más adaptada a tí.
Contacta con nosotros.

 Santiago Vega García1 y Clara Marín Orenga 2
Santiago Vega García1 y Clara Marín Orenga 2
1Catedrático de Sanidad Animal de la Facultad de Veterinaria de la Universidad CEU Cardenal Herrera de Valencia
2 Profesora Titular de la Facultad de Veterinaria de la Universidad CEU Cardenal Herrera de Valencia. Diplomada Europea en Avicultura
El término de Spillover (derrame en español) se ha utilizado desde tiempo inmemorial por los economistas para referirse a la idea de que algunos individuos o empresas se benefician (o perjudican) indirectamente de ciertas actividades o acciones realizadas por otros.


Sin embargo, desde la pandemia de SARS-CoV-2, este término ha saltado a la nomenclatura de uso habitual en medicina.
«Consiste en una situación en la cual un virus u otro patógeno, que es altamente prevalente en cierta especie animal, logra por el estrecho contacto con los humanos hacer el salto de esa especie animal al humano. El virus se adapta a una nueva población, en este caso la humana, eso es lo que se conoce como efecto Spillover (Figura 1)» - Zulma Cucunubá, investigadora del Imperial College de Londres.
Figura 1. El efecto spillover consiste en la transmisión de un virus u otro patógeno de animales a humanos.

Este fenómeno del derrame entre especies es la característica definitoria de los patógenos que se transmiten de los animales vertebrados a los humanos (zoonosis).
La transmisión por desbordamiento es promovida por procesos sucesivos que permiten que un patógeno animal establezca una infección en un ser humano.
La probabilidad de propagación zoonósica está determinada por las interacciones entre varios factores, incluida la dinámica de la enfermedad en el huésped reservorio, la exposición a patógenos y los factores humanos que afectan la susceptibilidad a las infecciones.
Todos los patógenos zoonósicos deberán superar una serie jerárquica de barreras que se oponen al flujo del patógeno desde el hospedador reservorio al nuevo y aún en él para causar infecciones indirectas en humanos.
La particularidad es que, en muchos patógenos, para que se produzca el salto de especie, éste debe superar todas las barreras a la vez, alineadamente y de manera sucesiva mientras que, en otros, de supervivencia prolongada en el ambiente (Bacillus anthracis) o de amplia difusión por aerosoles (Coxiella burnetii), el alineamiento se puede escalonar.
Comprender cómo estas barreras están vinculadas funcional y cuantitativamente, y cómo interactúan en el espacio y el tiempo, mejorará sustancialmente nuestra capacidad para predecir o prevenir estos eventos indirectos.




En el salto de especie se describen 3 niveles, que describen todas las principales rutas de transmisión (Figura 2).
Distribución e intensidad de infección en hospedadores reservorios
Distribución del hospedador del reservorio Densidad del hospedador reservorio Prevalencia de infección Intensidad de infección
Excreción Sacri cio
Transmitido por vectores
Liberación de patógenos de hospedadores reservorios
Supervivencia de patógenos, desarrollo y diseminación


Exposición humana a patógenos
Tasa de desprendimiento
Liberación patógenos y movimientos
Tasa de cosecha
Tasa de picadura ( vector del hospedador reservorio)
Susceptibilidad del hospedador
Comportamiento humano que permite contacto con patógeno
Presión patógena
Supervivencia patógenos y transporte de carne Despiece, preparación y consumo
Supervivencia de vectores y movimiento Tasa de picadura (vector - humano)
Barreras estructurales Respuesta inmune innata y compatibilidad molecular Ciclos completos de replicación y diseminación
Probabilidad de infección
El primer nivel está representado por el primer hospedador, enfermo o infectado, se incluirían aquellos de naturaleza ecológica, capaces de favorecer la dinámica de la enfermedad o la infección en el reservorio (y cuando existen vectores, también en ellos) gobernando la abundancia y difusión del patógeno.
Por ejemplo, se consideran la distribución y densidad de los reservorios, la coincidencia de hábitat con hospedadores nuevos, que proporciona oportunidades, la prevalencia y la intensidad de la infección.
En el segundo nivel, los factores condicionan lo que se denomina «presión del patógeno» que determina la exposición al hospedador nuevo.
A modo de ejemplo, se considera cuánto tiene que ver con la cantidad y calidad del patógeno, disponible para el hospedador nuevo (el hombre, si se trata de zoonosis) que, como se ha indicado, al final determina la exposición en lo que cuenta la disponibilidad de vías y una dosis suficiente.
La presión del patógeno se define a través de tres elementos;
Por un lado, la dinámica del patógeno en el reservorio, por ejemplo, su distribución en tejidos, órganos y sistemas y que está condicionada por la intensidad de la infección.
Por otro lado, las salidas disponibles al exterior, sea del animal vivo, de los animales sacrificados o de los cadáveres, y, finalmente, de la capacidad de supervivencia y, si existe, de reproducción o multiplicación en el exterior (Foto 1), todo lo cual al final condiciona también su dispersión en el ambiente (Plowright et al., 2017; Rodríguez Ferri, 2018).

El tercer nivel, representa la probabilidad de infección, que exige, por un lado, superar todas las barreras que le opone el hospedador nuevo (el hombre, en el caso de que se trate de un patógeno zoonósico), cuyo número es alto y su eficacia diversa.
Por ejemplo, se incluyen las barreras físicas, químicas y celulares que representan el fundamento de la inmunidad innata, a las que se suman las que corresponden a la inmunidad adaptativa.

En este sentido, también hay que considerar que la relación entre la dosis infectiva y la respuesta es donde se observan mayores oportunidades para el salto cuando las dosis son altas y la exposición es de corta duración.

A diferencia de cuando se trata de dosis bajas y mantenidas, dado el carácter sigmoide de la curva que representa la relación entre dosis y exposición.
 Foto 1. Segundo nivel del salto entre especies.
Foto 1. Segundo nivel del salto entre especies.
A partir de aquí, serán los cambios evolutivos que tienen lugar en el patógeno, los que determinen la capacidad de adaptación en el hospedador nuevo y, con ello, la posibilidad de transmisión intraespecie (transmisión interhumana, en el caso de los agentes de zoonosis).
Presión y exposicion dosis-vias
Favorecen la dinámica de la enfermedad en el hospeador-reservorio
Susceptibilidad probabilidad a la infección: barreras internas dosis-respuesta y conclusión

Las ventanas deben alinearse, y el salto es único Continuamente expuestos, la mayoria no infectan y si lo hacen es un suceso ocasional, sin adaptación ni transmisión interhumana
Un suceso excepcional, pero prima calidad sobre cantidad
hasta el nuevo hospedador e infectarle (modificado de Plowright et al. 2017).
Cada fase, como indicábamos anteriormente, presenta múltiples barreras para el flujo de un patógeno desde un huésped reservorio a un huésped receptor.
El desbordamiento requiere que el patógeno atraviese todas las barreras y, por lo tanto, solo puede ocurrir cuando los espacios se alinean en cada barrera sucesiva dentro de una ventana adecuada en el espacio y el tiempo (Figura 3).

· Eficacia probada por normas UNE oficiales europeas.

· 100% Estable.
· 100% Biodegradable.
Ecología animal, biología de poblaciones, biogeografía, ecología del comportamiento, ecología del paisaje y ciencias agrícolas.
Ecología de la enfermedad, epidemiología animal, dinámica de enfermedades infecciosas, inmunología, microbiología , medicina veterinaria.
Microbiología, ecología de las enfermedades, ecología de vectores, epidemiología, ecología espacial, dinámica enfermedades infecciosas. Epidemiología humana, antropología médica, ecología vectores, ciencias sociales, ecología del comportamiento, dinámica enfermedades infecciosas.
Microbiología, inmunología innata y adaptativa, biología celular de interacciones patógeno-hospedador, genéticas, biología evolutiva.
Distribución hospedador reservorio
Densidad hospedador reservorio
Prevalencia de patógenos
Intensidad de la infección
Supervivencia del patógeno en el hospedador
Supervivencia y propagación de patógenos
Exposición humana
Barreras estructurales
En consecuencia, el derrame zoonósico es un evento relativamente raro y, aunque los humanos están continuamente expuestos a muchos patógenos potencialmente infecciosos que se derivan de otras especies, la mayoría de estos microorganismos no pueden infectar ni causar enfermedades en los humanos.
Spillover

La probabilidad de propagación está determinada por las interacciones entre las barreras y los cuellos de botella asociados que podrían evitar la transmisión entre especies.
Muchas de estas interacciones son no lineales y dinámicas en el espacio y el tiempo.
Al menos 10 000 especies de virus tienen la capacidad de infectar a los humanos, pero, en la actualidad, la gran mayoría circula silenciosamente en los mamíferos salvajes.
Si bien, no todos los spillovers se convierten en una epidemia o pandemia, las condiciones actuales están aumentando las probabilidades de que esto ocurra.
Figura 4. Barreras al desbordamiento y relaciones dosis-respuesta. Fuente: Nature Reviews. Microbiology.Los animales de alto rendimiento como las cerdas, las gallinas ponedoras y las vacas lecheras, entre otros, se enfrentan a muchos factores de estrés, que pueden conducir a la inflamación crónica. A su vez, esto reduce la productividad y aumenta la huella ambiental. PhytriCare® IM es una mezcla de extractos de plantas cuidadosamente seleccionados con un contenido mínimo de 10% de flavonoides, diseñado para aliviar la inflamación. Gracias a estudios científicos hemos identificado los flavonoides adecuados que tienen efectos antiinflamatorios y son lo suficientemente pequeños como para ser digeridos y absorbidos fácilmente.
Sciencing the global food challenge. | evonik.com/phytricare

David Quammen argumenta que esta secuencia no es una mera concatenación de hechos fortuitos, sino que responde a efectos no intencionados de las actividades humanas, a la confluencia de una crisis ecológica y otra médica.
«No estamos ante una «venganza de la selva», sino de un proceso sin alma, una respuesta ciega a los cambios de los condicionantes naturales, la punta de lanza de unos derrames en los que potencialmente podrían llegar a involucrarse hasta unos cientos de miles de especies que pueden resultar patogénicas para los seres humanos.
Según el virólogo Luis Enjuanes, se estima que hay al menos trescientas veinte mil especies de virus de mamíferos en espera de ser descubiertos.
En un inventario reciente de especies patogénicas para los humanos, casi dos tercios de ellas resultan ser zoonósicas, la mayoría procedentes de reservorios no domésticos.
Los cambios en el clima y el uso de la tierra generarán oportunidades para compartir virus entre especies de vida silvestre previamente aisladas geográficamente.
En algunos casos, esto facilitará la propagación zoonósica, un vínculo mecánico entre el cambio ambiental global y la aparición de enfermedades.
Debido a su capacidad única de dispersión, los murciélagos representan la mayor parte del intercambio viral nuevo y es probable que compartan virus a lo largo de vías evolutivas que facilitarán la aparición futura en humanos.
Con nuestra invasión arrasadora del medio natural estamos propiciando los contactos necesarios para que se produzcan estos trasvases.
No es que los patógenos estén invadiendo nuestro hábitat, sino que nosotros estamos invadiendo el suyo.
Lo peor puede ciertamente estar por llegar.
Hoy tenemos claro que hay una relación muy estrecha entre el comercio internacional y las enfermedades emergentes y tenemos que defender la consolidación de la idea de una sola salud global «One World, One Health» que proteja a la vez ecosistemas, fauna y humanos (Peter Daszak-Alianza Ecohealth).
El desarrollo económico de muchos países está haciendo que las personas invadan la vida silvestre.
Puede que la epidemia de COVID-19 empezará con un murciélago, pero fue la actividad humana la que lo dejó suelto.

Es por ello por lo que en las zonas tropicales y selváticas donde hay mayor interacción con los animales, es más probable que los humanos pueden adquirir distintos patógenos que conducen a una enfermedad.
Si bien los animales pueden ser transmisores de virus, para los expertos citados la causa de las enfermedades también radica en qué tipo de interacciones tienen los humanos con las especies.



Las pandemias tienen lugar cuando abrimos brechas en la naturaleza de forma desbordada e incontrolada, como las que causan el comercio, la caza y el consumo de animales silvestres, la deforestación o la sobreexplotación ganadera.
Todo ello rompe el efecto protector de la biodiversidad y favorece el trasvase de patógenos.
A esto hay que sumar un elemento crucial, la cada vez más alta densidad de población humana y su movilidad sin precedentes que promueven infinidad de vías de contagio, junto con el calentamiento global del planeta.


Todo lo anterior nos lleva a pensar que cada vez vamos a tener más spillovers, cuanto mayor sea el número de estos eventos mayor será la probabilidad de que tengamos más epidemias o/y pandemias en el futuro.

La propagación de patógenos ambientales o animales en las poblaciones humanas es un proceso
En vista de las tendencias antropogénicas actuales, un enfoque más efectivo para la prevención y el control de enfermedades zoonósicas requerirá una visión amplia de la medicina que enfatice la toma de decisiones basada en evidencia e integre los principios ecológicos y evolutivos de los factores animales, humanos y ambientales, este concepto es lo que actualmente se conoce como estrategia «One Health».

Esta visión amplia es esencial para el desarrollo exitoso de políticas y prácticas que reduzcan la probabilidad de futuras emergencias zoonósicas, la vigilancia específica y la prevención estratégica.
De la misma manera, es necesaria la participación de socios fuera de la comunidad médica para ayudar a mejorar los resultados de salud y reducir las amenazas de enfermedades.
Este proceso de propagación es estocástico y, desde la perspectiva del éxito del patógeno, bastante imperfecto
La mayoría de los virus de los mamíferos carecen de la capacidad de infectar incluso a los humanos, y la mayoría de los eventos indirectos que ocurren no logran establecer una infección circulante en el nuevo huésped.
A pesar de la larga y compleja historia de pueblos y plagas, el consenso científico indica que la tasa de aparición de enfermedades infecciosas se ha acelerado en la historia más reciente.
Diferenciar la próxima pandemia del ruido de fondo es un desafío casi insuperable y continúa a medida que evolucionan o se descubren nuevos patógenos.
Las reglas generales básicas están bien establecidas, de modo que los virus de ARN monocatenario están predispuestos a convertirse en zoonóticos, probablemente debido a una predisposición a la capacidad de evolución y al cambio de huésped.

Video: What is spillover? Fuente: Istituto Zooprofilattico Sperimentale delle Venezie (IZSVe). Italian health authority and research organization for animal health and food safety.
La importancia del análisis de los datos de embriodiagnosis para la gestión de la planta de incubación DESCÁRGALO EN PDF
©Este artículo no se ha escrito con ninguna herramienta de inteligencia artificial.


arriba a abajo y crean
mente sobre los animales, inación con la forma ideal también para una

D O R alurosos. ble.
mento


idas de alimento rio de las manadas dad del alimento.

1Coordinadora y Resp. Calidad CECAV

2Director gerente CECAV
Salmonella es reconocida como un importante patógeno zoonótico transmitido por alimentos, con importancia económica tanto en animales como en humanos (García et al., 2018)
Son bacterias Gram negativas, forman parte de las γ-Proteobacterias y pertenecen al género Salmonella de la familia Enterobacteriaceae (Garrity et al., 2004).

Se consideran dos especies del género Salmonella: S. enterica y S. bongori.

Dentro de la especie S. enterica se distinguen 6 subespecies o subgrupos fenotípicamente distintos: enterica (I), salamae (II), arizonae (IIIa), diarizonae (IIIb), houtenae (IV) indica (VI).
Dieciséis Estados miembros e Irlanda del Norte lograron todos los objetivos establecidos en las poblaciones de aves de corral para la reducción de la prevalencia de Salmonella para los serovares relevantes.
Salmonella se identificó como agente causal en la mayoría de los brotes de origen alimentario en la UE (N = 773), lo que representa el 19,3 % del total de brotes.
Dentro de cada subespecie se separan, en función de sus respuestas serológicas, distintos serotipos o serovares (Le Minor y Popoff, 1987; Grimont y Weill, 2007)
El informe comunitario sobre zoonosis de la Unión Europea One Health de 2021 publicado en diciembre de 2022 por la European Food Safety Authority (EFSA) señala la campilobacteriosis y la salmonelosis como primera y segunda zoonosis más notificadas en humanos (el número de casos de campilobacteriosis ha sido de 127.840 y de salmonelosis 60.050, respectivamente).
Los casos de campilobacteriosis y salmonelosis aumentaron en relación con 2020, pero disminuyeron comparando con años anteriores.
Este patógeno también se asoció con el mayor número de casos (20,8% de los casos asociados a brotes) y hospitalizaciones (45,0% de las hospitalizaciones asociadas a brotes). S. Enteritidis fue el serotipo predominante (N = 350; 79,7 % de todos los brotes de Salmonella).
Los huevos y los ovoproductos se confirmaron como la principal fuente de brotes de salmonelosis en 2021, al igual que en años anteriores. También la carne de pollo de engorde es otra fuente de Salmonella (EFSA, 2022).

Su pH de acción se sitúa entre 4 y 10
Se puede utilizar en presencia de acidificantes. No reacciona con amoníaco o sales de amonio.

Apto para cualquier tipo de tubería pues no provoca corrosión. No genera olores ni altera el sabor del agua.
Es tan efectivo que requiere muy poco tiempo de contacto. Elimina el biofilm.
Alta solubilidad.
Producto no ADR sin limitaciones de transporte.
Pica d’Estats, 22, 3-2 · 25006 Lleida · T/F: 973 260 198 arvet@arvet.eu www.arvet.eu
De conformidad con el Reglamento (CE) n.º 2160/2003 y sus modificaciones posteriores, los estados miembros de la Unión Europea han establecido programas nacionales de control de Salmonella (PNCS) destinados a reducir la prevalencia de los serovares de Salmonella que se consideran relevantes para la salud pública.
Actualmente, se han definido objetivos de prevalencia para manadas reproductoras de Gallus gallus, gallinas ponedoras, pollos de engorde y pavos reproductores y de engorde. Estas corresponden al porcentaje máximo anual de manadas positivas para S. Enteritidis y S. Typhimurium, incluida su variante monofásica, a excepción de las reproductoras de Gallus gallus, donde S. Infantis, S. Virchow y S. Hadar también se consideran relevantes.

El objetivo de prevalencia es igual al 1% o menos para reproductoras de Gallus gallus, pollos de engorde y pavos reproductores y de engorde; es del 2% para las gallinas ponedoras.
En este contexto se han estudiado las prevalencias obtenidas de las muestras analizadas en CECAV (Centro de Calidad Avícola y Alimentación Animal de la Comunidad Valenciana, laboratorio autorizado para la realización de las muestras de los PNCS) y los serotipos detectados, desde 2017 a 2022.
Los métodos de detección de Salmonella que se aplicaron a las muestras pertenecientes a los PNCS que se han analizado en CECAV fueron la UNE-EN ISO 6579-1 e iQCheck PCR Salmonella (Bio-rad).
La preparación de las muestras previa al análisis se realizó siguiendo las directrices de la UNE-EN ISO 6887-6.
Tras la detección de Salmonella, las cepas aisladas fueron serotipadas según la UNE-CEN ISO/TR 6579-3:2015 IN.
Todos los resultados obtenidos se grabaron en la aplicación informática de autocontroles desarrollada por el Ministerio de Agricultura, Pesca y Alimentación para comunicar los resultados por parte de los laboratorios autorizados.


Se presentaron diferentes patrones en el número de positivos de Salmonella de muestras de los PNCS en los distintos años dentro del periodo analizado.
En 2017 y 2020 se observaron valores más bajos en el primer semestre del año con aumento de la prevalencia en los meses de verano, posterior descenso desde el valor máximo y nuevo aumento hasta final de año.

En 2018, 2019 y 2021 se sigue el mismo patrón que en 2017 y 2020, pero con la diferencia de que no se presentó la subida en los meses finales del año, sino que presentó una tendencia a la baja.
En 2022, el patrón es diferente a los años anteriores, ya que se observan valores bajos hasta el mes de mayo, con aumento progresivo desde este mes hasta noviembre y ligero descenso en diciembre.
Aunque la detección de diferentes cepas de Salmonella se da durante todo el año y con diferentes patrones, la mayor cantidad de aislados se han obtenido durante los meses correspondientes a verano y otoño, disminuyendo en general durante la época de invierno, observando estacionalidad.

Teniendo en cuenta el informe comunitario sobre zoonosis de la Unión Europea One Health de 2021 publicado en diciembre de 2022, se observó una tendencia estacional de casos confirmados de salmonelosis en la Unión Europea entre 2012 y 2021, con más casos notificados durante los meses de verano (EFSA, 2022).
Otros autores, como Murray et al. en 2021, estudiaron las tendencias temporales de muestras de criaderos de aves observando que las mayores probabilidades de que S. enterica ocurra es en verano y otoño
Descenso de hasta un 90% de la carga microbiana
Perfecta combinación de tensoactivos, hidróxidos, ácidos y secuestrantes para cada aplicación
Degradan biofilms e incrustaciones de sales imposibles de eliminar sólo con agua






Facilitan el aclarado y la desinfección posterior











El número de positivos de Salmonella spp y los valores máximos de positivos de Salmonella spp. en los años 2017 a 2022 siguen la misma tendencia.


Estos valores disminuyen de forma brusca de 2018 a 2019, luego aumentan hasta 2021 y disminuyen de nuevo en 2022.

El serotipo más prevalente fue Infantis en todos los años a excepción de 2017, que fue Senftenberg (en 2017 Infantis estuvo en segundo lugar).
En cuanto a los casos en la Unión Europea en 2021 reflejados en el informe de la EFSA publicado en 2022, S. Infantis ha sido la cuarta serovariedad más frecuentemente informada involucrada en infecciones humanas.
Los tres serovares humanos más frecuentes han sido S. Enteriditis, S. Typhimurium y su variante monofásica (1,4,[5],12:i:-) que representan más del 70% de los casos humanos en la Unión Europea, como se viene observando desde 2014, alcanzando el 79,1% en 2021. (EFSA, 2022).
Algunos autores señalan Infantis como un serotipo emergente debido a la presencia de genes de resistencia y de virulencia (Dos Santos et al., 2021; Bojan et al., 2022; Lapierre et y la contaminación granjas de pollos de engorde se serotipos (Mughini-Gras
Salmonella ha sido y sigue siendo un importante agente zoonótico transmitido por los alimentos, aunque es cierto que la prevalencia de infecciones en humanos ha disminuido significativamente en todo el mundo durante la última década.

Los principales serotipos asociados a infecciones en humanos son Enteritidis y Typhimurium, el primero procedente principalmente de huevos, el último de carne porcina y de aves, entre otras fuentes (EFSA, 2022) En la última década han surgido otros serotipos a nivel regional y mundial.




El aumento global de Salmonella Infantis ha causado preocupación, ya que poblaciones clonales altamente resistentes a los antimicrobianos y portadoras de factores de virulencia codificados por plásmidos se han identificado a nivel global en poblaciones de pollos (Alba et al., 2020; Guerrero et al., 2022).
Este ha sido el principal serotipo aislado en la carne y granjas de pollos, aproximadamente representa el 50% de todos los aislamientos (EFSA, 2022).
Aunque esto todavía no ha provocado un fuerte aumento de los casos de intoxicación alimentaria humana, Salmonella Infantis se ha convertido en el tercer serotipo causante de intoxicación alimentaria humana (EFSA, 2022).
El plásmido que está presente en los nuevos clones emergentes también se ha transferido a otros serotipos, según informes recientes, lo que hace que el problema sea potencialmente mayor de lo previsto inicialmente (Dos Santos et al., 2022).
Además, a menudo se encuentra en la carne de pollo en los mataderos, lo que tiene implicaciones ya que la carne fresca de pollo debe estar libre de Salmonella
Salmonella Infantis es uno de los 5 serotipos regulados por la legislación de la UE, y las reproductoras que también son susceptibles de ser colonizadas han de presentar ausencia de este serotipo.
Si bien los nuevos clones emergentes de Salmonella Infantis (y otros, por ejemplo, Paratyphi B, Heidelberg) persisten en gran medida en las granjas de pollos y, por lo tanto, la contaminación ambiental y la propagación horizontal son importantes, también las ponedoras y las reproductoras pueden ser colonizadas.
Estas últimas pueden contribuir potencialmente a la transmisión vertical (a través del huevo), aunque los informes existentes son escasos (Lapuz et al., 2012, Calero-Cáceres et al., 2020).
Si bien la bioseguridad y el manejo son clave para el control de la infección en las granjas (y en los mataderos), la protección de ponedoras y reproductoras también puede contribuir a la reducción de la prevalencia de Salmonella Infantis.
Las vacunas utilizadas actualmente se basan principalmente en antígenos o cepas vivas de Salmonella Enteritidis o Typhimurium, ya que estos han sido los principales serotipos que contribuyen a las infecciones humanas.

Una de las principales dudas que ha surgido es si también se puede inducir la protección cruzada frente a otros serotipos de importancia mundial.
Salmonella se clasifica en serogrupos según la presencia de antígenos lipopolisacáridos (LPS) y, además, en serotipos según los antígenos LPS y flagelina.


Se describen más de 2000 serotipos y, aunque la mayoría puede causar infecciones en humanos, solo una docena se aísla con frecuencia de casos y brotes en humanos.
Siempre se ha creído que las del mismo serotipo una mejor protección contra las cepas del mismo serotipo (o serogrupo).
Inicialmente, en base a estudios de vacunas entre serotipos, muestran que las vacunas contra Salmonella Enteritidis y Gallinarum confieren protección cruzada entre sí.
Además, varios estudios muestran protección entre serogrupos, usando preparaciones de vacunas de un solo serotipo o vacunas que usan cepas de múltiples serotipos en una sola vacuna viva.
Esto parece lógico, ya que se comparten muchos antígenos entre diferentes serotipos de Salmonella y las respuestas inmunitarias humorales y mediadas por células se dirigirán a una gran cantidad de serotipos de Salmonella.
Los ejemplos de estudios sobre protección cruzada son numerosos.
Por ejemplo, Lee (2015) observó que después de la vacunación oral a ponedoras, con una cepa atenuada de Salmonella Typhimurium a los 7 días de edad seguida de una dosis de refuerzo a las 4 semanas, se originó una respuesta de anticuerpos significativa a los antígenos contra los serotipos Typhimurium, Gallinarum y Enteritidis.
Del mismo modo, se presenciaron respuestas linfoproliferativas significativas a los 3 serovares de Salmonella.
En este estudio, tras el desafío de Salmonella Gallinarum, el grupo inmunizado mostró:
Una mortalidad significativamente menor en comparación con el grupo no inmunizado.
Una persistencia reducida de Salmonella Typhimurium y Enteritidis en ciegos y órganos internos, mostrando una clara protección cruzada.

También, se ha demostrado que la administración oral de una vacuna viva bivalente de Salmonella Enteritidis/ Typhimurium causa una reducción de la colonización cecal por Salmonella Enteritidis y Infantis, esta última a niveles muy bajos, que estaban cerca del límite de detección (Eeckhaut et al., 2018).
En este estudio la vacuna viva bivalente de Salmonella Enteritidis/Typhimurium fue administrada a las aves dos veces (el día 1 y la semana 6) y tres veces (el día 1, la semana 6 y 16). La infección fue en la semana 7 y 17, respectivamente.
Ambos estudios evidenciaron un nivel medio de colonización cecal por Salmonella de aproximadamente 10⁵ ufc/g en aves no vacunadas, mientras que la vacunación lo redujo a niveles que solo podían detectarse después de usarse cultivos de enriquecimiento.

Este estudio muestra una clara protección cruzada entre las vacunas con Enteritidis y Typhimurium y otros serotipos, en este caso Salmonella Infantis, un serotipo de un serogrupo diferente en comparación con Enteritidis y Typhimurium.
A pesar de que son necesarios estudios que lo confirmen, se espera que cuando se añaden múltiples serotipos a una preparación vacunal se puede inducir una protección cruzada más fuerte, ya que podrían estar presentes más antígenos.
Otros estudios refieren efectos de protección cruzada similares, por lo que la base científica es evidente.
Figura 2. Colonización cecal por Salmonella Infantis o Salmonella Enteritidis en aves no vacunadas y en aves vacunadas con una vacuna viva bivalente de Salmonella Enteritidis/Typhimurium, y desafiadas siete días después de la vacunación con 5x10⁸ ufc de Salmonella Enteritidis y 4,6x10⁸ ufc de Salmonella Infantis.
En conclusión, las vacunas contra Salmonella no solo pueden proporcionar protección entre serotipos, sino que también pueden conferir protección contra otros serotipos.
Todavía no se ha investigado si este es el caso para cualquier serotipo. Por lo tanto, es necesario realizar más estudios para respaldar esta afirmación, pero dado que muchos antígenos compartidos están presentes en las cepas de todos los serotipos de Salmonella, es de esperar la existencia de protección cruzada.
Es importante recordar también que las estrategias de vacunación son altamente eficientes para controlar la presencia de Salmonella en lotes de ponedoras y reproductoras siempre que vayan unidas a una estrategia adecuada de bioseguridad y manejo.
Importancia de la protección cruzada inducida por vacunas en la prevención de Salmonella en ponedoras y reproductoras DESCÁRGALO EN PDF





1Nutrition. Global Technical Service Lohmann Breeders

2Ibertec
Se ha escrito mucho acerca de la importancia de la recría como periodo de preparación para lo que luego ha de venir: ciclos más largos con una mayor productividad mientras se mantiene la calidad del huevo.
Este periodo de preparación ha sido considerado tradicionalmente como un gasto, más que como una inversión, teniendo como único objetivo recriar al ave para alcanzar en el mejor de los casos el peso establecido y comenzar la producción lo antes posible.
El periodo de recría comienza desde el mismo momento de la recepción hasta la semana 30, momento en el que la ganancia de peso vivo es prácticamente nula y, por tanto, decimos que el ave es madura.
Durante este periodo, hay una serie de factores que nos “acercará o alejará” del objetivo:
Disponibilidad y calidad del agua.
Condiciones a la recepción como la temperatura y la humedad en el momento de la llegada de la pollita.
La densidad de la nave: mayor densidad, menor oportunidad de acceder al comedero/ bebedero lo que limitará el crecimiento.
Formato y presentación del pienso. Presentaciones más finas: menor consumo.
Estrés: temperatura, densidad, falta de nutrientes (aminoácidos, fibra insoluble, etc.)


Manejo del pienso: cantidad y número de pasadas.
Aquí, se ha de considerar también la densidad del pienso: a menor energía (y, generalmente mayor aporte de fibra), más volumen-menor densidad. ¿mayor número de repartos/cantidad?

Esto es lo que denominamos PERIODO DE PREPARACIÓN.
Pero centrémonos en los momentos importantes:
A estas alturas nadie duda de su importancia dado que es durante las primeras 5 semanas de vida cuando se forman órganos clave, tales como el hígado, riñón, pulmones, etc.
Durante las primeras 6 semanas se establece la microbiota intestinal y durante las tres primeras se produce el desarrollo del sistema inmune.


El diseño de la dieta inicial y su uso (no debemos de olvidar que es la más concentrada en cuanto a densidad nutricional – energía y aminoácidos) viene condicionado por el desarrollo corporal durante las primeras semanas de vida.
Por tanto, ante cualquier retraso en el crecimiento, parecería lógico extender su uso, ¿no?
Este desarrollo viene condicionado por el nivel de energía, pero, sobre todo, por el perfil aminoacídico.
En el trabajo de Cheng y Coon (1991) queda reflejado como, siendo la energía importante, cualquier deficiencia en cuanto a proteína/ aminoácidos (especialmente los sulfurados) afectará notablemente el crecimiento.
 Gráfica 1. Ganancia de peso vivo vs energía/nivel aminoácidos-proteína. Cheng y Coon (1991).
Gráfica 1. Ganancia de peso vivo vs energía/nivel aminoácidos-proteína. Cheng y Coon (1991).


















De forma ideal, una harina homogénea satisface las necesidades de la pollita al tiempo que desarrolla el digestivo mientras que una harina con un porcentaje de finos elevado (≥15% por debajo de 1 mm de diámetro) afectará al consumo y, por tanto, al crecimiento.

Las aves, incluso durante la fase de recría, tienen una marcada preferencia por las partículas más groseras (Portella y col., 1998).
VARIACIÓN EN LA COMPOSICIÓN
En este sentido, es interesante ver en la Gráfica 2 la composición de las distintas fracciones que componen un pienso de arranque comercial (harina de 0 a 5 semanas).
Además de los resultados de la gráfica, el contenido en sodio de la fracción entre 2.5 - 1 mm diámetro resultó ser de 0.14% frente al 0.22% de la fracción por debajo de 1 mm de diámetro.
En base a las diferencias, si las pollitas seleccionan, la ingesta de nutrientes será diferente. Por tanto también lo será su crecimiento y desarrollo.
Gráfica 2. Variación en la composición de las distintas fracciones de un pienso de arranque comercial (Servicio Técnico de Lohmann Breeders, 2022).
Más allá de la concentración, es importante la presentación del alimento.
Ante esta situación, una buena migaja con el mismo condicionante en cuanto a la distribución de partículas, se presenta como una buena alternativa. Gráfica 3.
En esta primera fase, además de poner la máxima atención en el diseño de las dietas, tenemos que ser capaces de adaptar los manejos de pienso/dieta a las necesidades que requiere el lote.
Partimos de sistemas donde normalmente se alojan aves en un único nivel o en los que el diseño de estos no permite inicialmente el acceso ni a toda la superficie del sistema ni a todos los elementos de este (líneas de comedero/bebedero).

Es por ello por lo que debemos de insistir en el manejo del pienso para que la pollita tenga un fácil y continuo acceso al mismo sobre todo durante este periodo inicial.

Además, tenemos que recordar el tratamiento de picos qué, en la mayoría de los casos, se hace en sala de incubación y no deja de ser una “incomodidad” más para la pollita.


La provisión de un nivel adecuado de alimento en el comedero y/o la distribución y reposición de este sobre el papel del sistema en los días posteriores a la llegada de las pollitas facilitará de forma clara el consumo inicial que buscamos.

Otro momento clave, dentro de las primeras 6 semanas de vida, es la apertura de los sistemas que permite el acceso de las pollitas al suelo.
En este momento las pollitas deben de comenzar a familiarizarse con un entorno nuevo que es el suelo.
Aquí no van a encontrar ni alimento ni agua, lo que provocará un retraso en el consumo y en el desarrollo (pasarán varios días) hasta que se habitúen a acceder al sistema.

Durante este periodo, debemos de ser más conservadores en los manejos del pienso: es recomendable mantener la dieta (composición y presentación) que estén comiendo en ese momento.
Bajo esta situación, el acceso de las pollitas al sistema será de una forma más irregular por lo que es recomendable que haya siempre pienso en el comedero retrasando, por tanto, el vacío de comedero.







DESCRIPCIÓN: AVIFOS SP es una solución oral, que contiene una concentración elevada y bien equilibrada de calcio-fósforo y oligoelementos esenciales para el organismo. La atención principal se centra en aquellos elementos que interfieren o están relacionados con el metabolismo del calcio, cáscara del huevo y formación del esqueleto, entre otros. Los minerales son bien asimilados por el organismo. ESPECIES DE DESTINO E INDICACIONES: • Aves: Enfermedades que afectan la formación de los huesos, fortaleza de las articulaciones, calidad de la cáscara del huevo, y picos de puesta. VÍA DE ADMINISTRACIÓN Y DOSIS:Vía oral en el agua de bebida a la dosis de 0,5 – 1 ml. AVIFOS SP / L agua de bebida durante 7 – 10 días. INTERACCIONES: No administrar AVIFOS SP junto con tetraciclinas, sales de calcio. Debido a su elevada concentración de fósforo el pH del producto es bajo (ácido). PERIODO DE SUPRESIÓN: No aplicable. AVIFOS SP es un suplemento nutricional. PRESENTACIONES: envases de 5 L. La solución tiene una larga estabilidad.






5 s 10 s 15 s
Gráfica 5. Curva de ganancia de peso vivo ideal y <<compensatoria>>.

Siguiendo el análisis de la gráfica 3, a partir de la semana 10, la demanda de nutrientes es menor.
En este periodo podemos “relajar” la densidad de nutrientes, en particular la energía dejando espacio para la incorporación de fibra, que potenciará ambos desarrollos.
Con frecuencia nos encontramos con lotes de pollitas cuya curva de crecimiento difiere de las propuestas por las guías de manejo: por debajo de lo recomendado hasta la semana 10.
A partir de ese momento, se produce una “recuperación” para alcanzar el peso vivo establecido o, ligeramente por debajo, a la semana 17 (Ver Gráfica 5).

Gráfica 6. Efecto de la incorporación de fibra insoluble (Fibra Neutro Detergente –FND) sobre la composición corporal de las pollitas. Freitas y col. (2014).

Casi siempre, esta recuperación va a acompañada de dietas de alta densidad tratando de compensar las diferencias con las guías presentando los siguientes inconvenientes:
La alta densidad nutricional no deja lugar para la incorporación de la fibra insoluble (FND) por lo que se limitan tanto el desarrollo del digestivo como la capacidad de consumo, factores claves para los sistemas libres de jaula.
El uso de dietas con elevada densidad nutricional, y menor contenido en FND, durante este periodo está relacionado
La dieta de alta densidad nutricional implica un aumento de energía y/o aminoácidos, los dos nutrientes más caros de la dieta, por lo que tiene un coste elevado.

Si consideramos la Gráfica 2, el IC acumulado durante ese periodo duplica al de las primeras 10 semanas y la fisiología del ave nos dice que el momento de máximo desarrollo ya no tiene lugar.
Además, este periodo (10-15 semanas) representa el 50% del consumo de pienso durante la recría: ¿tiene sentido seguir concentrando la dieta en esta fase?
El uso de dietas con mayor concentración energética durante este periodo conlleva un menor consumo acumulado además de una menor uniformidad (Keshavarz,1998).


Desde el punto de vista económico y por las repercusiones que tiene sobre el crecimiento, es más interesante invertir en dietas de mejor calidad durante las primeras 10 semanas de vida a la vez que manejamos las mismas adaptándolas a la situación-evolución de cada lote.
Esto nos permite rebajar la densidad del pienso durante la segunda parte de la recría a la vez que fomentamos el desarrollo intestinal y la capacidad de consumo, ambos fundamentales para un buen comienzo de la producción.
periodo de preparación DESCÁRGALO EN PDF



Solmediat ofrece soluciones integrales para la gestión inteligente del estiércol, purines, lodos y residuos orgánicos.

Solmediat nace fruto de más de 40 años de experiencia en el sector ganadero. Como respuesta a una problemática actual, cuando hemos sido capaces de darnos cuenta que el cambio climático es real.
No podemos ni tan siquiera plantearnos que la solución a nuestro problema pueda pasar por el “amontonamiento” de los residuos orgánicos en vertederos o su utilización directa para la agricultura, siendo el sector primario con gases como el metano, el nitrógeno y el dióxido de carbono, uno de los principales responsables.

Es por esto que nuestra andadura ha estado siempre marcada por la búsqueda de una solución final y definitiva.
Por eso, nuestras investigaciones han ido dirigidas no solo a la eliminación del residuo en sí en un espacio lo suficientemente reducido, sino a procurar que este proceso fuera el más amigable con el medio ambiente, con la comunidad y la vida diaria.
Además, hemos sido conscientes, no solamente de nuestra realidad medioambiental hacia arriba (cielo), sino también hacia abajo (suelo).
Cuando hablamos de contaminación o medioambiente normalmente pensamos en el cielo, pero.. ¿y nuestro suelo?
Nuestro suelo requiere un aporte de materia orgánica continuado. Este aporte extra de materia orgánica al suelo en forma de compost no solamente es beneficioso, sino también

Ser capaces de reutilizar nuestros desechos, reduciendo su espacio y aprovechando el resultado para aportar nuestro grano de arena en la lucha contra la desertización y el favorecimiento de la agricultura , es el verdadero sentido de la economía circular y sostenible.

La legislación vigente exige que el estiércol, para su utilización como fertilizante, sea sometido a un proceso de pasteurización a una temperatura superior a 70ºC durante un tiempo no inferior a 1 hora.
Con esto, se consigue la eliminación de los patógenos y bacterias, obteniendo un producto final seguro y estable para un abono orgánico totalmente higiénico.
Además, se debe de llevar un registro histórico de temperaturas.
La serie Ceres está equipada con un sistema electrónico que suministra el oxígeno encargado de regular la temperatura para conseguir que el material se mantenga a una temperatura superior a 70 grados.
Además, esta temperatura queda registrada en nuestro software, en un registro accesible desde la nube de forma remota, mediante PC o App móvil.
Esta monitorización permite aumentar la seguridad ante cualquier organismo, aportando a cada cliente un registro real de temperaturas. De la misma manera, como no se pueden manipular, son el fiel reflejo de la realidad sin margen de error.

El producto (estiércol) es introducido diariamente según la capacidad de la torre, que puede ir desde los 7m3 hasta los 45m3 diarios, aproximadamente.
Un sistema computerizado regula la cantidad de oxígeno y la temperatura a la que este es introducido, que oscila entre 70ºC y 90ºC Los gases son expulsados a un sistema de limpieza que elimina la mayor parte de los olores.


El proceso completo dura tan solo “7 días”, aunque una vez comenzado el funcionamiento, cada día introducimos materia prima y sacamos compost.
Mediante unas aspas, el producto es agitado y aireado.
La temperatura, asistida por computadora, es registrada en varios puntos del reactor para controlar y monitorizar las diferentes fases del proceso.

Diariamente, se descarga el compost en una relación de 3 a 1, aproximadamente.
Con el sistema ZEUS CLOUD, se pueden gestionar nuestros equipos en vivo, además de obtener históricos de funcionamiento, generación de gráficas o históricos de temperaturas y alarmas con notificaciones.
Control de temperatura computerizada Higieniza los residuos eliminando las bactérias y los patógenos
 Figura 2. Temperatura.
Figura 3. Control temperatura.
Figura 2. Temperatura.
Figura 3. Control temperatura.
Generación de gráficas

Gestión remota de equipo Descarga de históricos
Con ZEUS CLOUD podrá seleccionar diferentes programas de compostaje, como modos de ahorro energéticos, modos diurnos para gestión con placas fotovoltaicas, etc.

Nuestro continuo desarrollo y apertura a nuevas ideas le permite a usted como cliente poder solicitar personalizaciones de aplicaciones adaptadas a sus necesidades.
personal especializado para adaptar nuestro compost a las exigencias y necesidades de cada agricultor.
Nuestros equipos fueron desde el principio desarrollados con la mayor calidad posible.
Los estiércoles, principalmente el de gallina, son extremadamente corrosivos y por ello fue nuestra premisa no escatimar ni la calidad del material ni en el diseño estructural del mismo.
Autogestión
Modo ahorro noche
Pondrá el modo ahorro de 21:00 a 7:00
Modo ahorro diurno
TORRE 2
Configuración
Avanzada
Alarmas
Nuestro equipo está cualificado para diseñar y adaptar las instalaciones a cualquier público, desde un granjero individual hasta grandes instalaciones para gestores de residuos.


Controlando y gestionando sus propios “desechos” evitará la acción de terceros agentes que interfieran en el buen control sanitario de su instalación.
El acceso no controlado a sus instalaciones de los gestores de residuos y de transportes, entre otros, que previamente han estado en contacto con otros focos de infección, multiplican de forma exponencial el riesgo de introducir patógenos procedentes de otras instalaciones.
Tenga siempre en cuenta que todos agentes que gestionan su residuo han estado en contacto con el foco más contagioso existe en cualquier explotación ganadera, que son las heces de animales.
Figura 4. Funcionamiento Zeus Cloud. Figura 5. Diferentes programas de compostaje y ahorro energéticoNuestros reactores proveen una temperatura del aire comprendida entre 70 y 90 grados.
Esto significa que tanto las moscas como las “inmortales” larvas de las mismas son destruidas en cuestión de segundos, pasando a engrosar la lista de nutrientes del futuro compost.
Los reactores de compostaje vertical CERES, pueden venir equipados con diferentes sistemas desodorizantes, que eliminan la mayor parte de los malos olores.
Trabajamos continuamente para desarrollar nuevos filtros y componentes que nos hagan llegar a la eficiencia completa en este aspecto.
La familia de reactores de compostaje vertical Ceres es un ambicioso proyecto de un equipo joven y diversificado, con un conocimiento exhaustivo del sector y una mente abierta a las nuevas tecnologías, en una sociedad que nos lleva hacia un rumbo que debemos enfocarlo en la “autosuficiencia”.




En un mundo tan limitado y sensible, debemos ser capaces de entender este nuevo concepto, cuyo objetivo es borrar la huella que dejamos solo por el mero hecho de intentar subsistir y devolver a la tierra lo que de alguna manera ella nos ha dado.
Nacemos de la sinergia de dos grandes empresas de dos países diferentes, que se sienten orgullosos de haber sido capaces de intercambiar informaciones, experiencias y esfuerzos para desarrollar unos equipos funcionales, resolutivos y del más alto nivel.
También nos enorgullece haber logrado, gracias a esta sinergia, cumplir el objetivo por el que cada una de estas empresas fue creada: ayudar al sector primario a la vez que aportamos nuestro granito de arena a la economía circular.
Ceres es la adecuación patentada y registrada por Solmediat, empresa 100% española, de una invención asiática para su adaptación a los estándares europeos de calidad, seguridad en máquinas y seguridad laboral.
Al igual que su correcta adecuación en el cumplimiento de las normas fitosanitarias en control de eliminación de patógenos y bacterias, dando lugar a un producto final higienizado con un control absoluto y automatizado del proceso de producción.

Estamos muy orgullosos de haber logrado diseñar, registrar y patentar las adecuaciones necesarias para obtener un equipo funcional, seguro e higiénico, capaz de certificar las normativas más exigentes.
 Figura 6. Sistema desodorizante que elimina la mayor parte de los malos olores.
Figura 6. Sistema desodorizante que elimina la mayor parte de los malos olores.
en la gestión del estiércol y, además, obtener un valor añadido y, por ende, un rédito económico, es el principal motivo por el que todas las explotaciones ganaderas de cierto nivel deberían disponer de un equipo Ceres.
Siempre que hablamos de gases de efecto invernadero pensamos en el CO₂, pero nos olvidamos que el óxido de nitrógeno es 300 veces más potente que el CO₂ o que el Metano es casi 30 veces más potente que el CO₂, en lo que a efecto invernadero se refiere.

¿Qué precio tiene utilizar nuestro estiércol fresco directamente en la agricultura? ¿Qué precio tiene llevar nuestro estiércol a un vertedero?
Nuestro modelo estrella tiene 105m 3 con el que se pueden gestionar algo más de 100.000 gallinas, pero disponemos de un modelo más grande con 280m 3 con el que se pueden gestionar alrededor de 300.000 gallinas, todo esto siempre supeditado a la humedad.
Para más información sobre CERES, escanea el siguiente QR!
Ciertamente en estos 2 escenarios se llevará a cabo un proceso de fermentación anaeróbica en la que la emisión de estos 3 gases estará presente
Tabla 1. Capacidad de los distintos modelos“Quitarse un problema de encima” como


PROTECTING THE PLANET FOR FUTURE GENERATIONS
EFICIENCIA MEJORADA
El pollo moderno es más eficiente biológicamente por kg de peso vivo: 40
320 gr.
gr.
EXTRA DE RENDIMIENTO CÁRNICO
MENOS DE ALIMENTO USO DEL AGUA
Y además se incrementan la viabilidad, la salud y el bienestar animal a través de la selección balanceada
POTENCIAL DE CALENTAMIENTO GLOBAL REDUCIDO
Mejora en Índice de Conversión y periodos de crías más cortos =
19 %
DE REDUCCIÓN
DE EMISIONES DE GASES DE EFECTO INVERNADERO
REDUCCIÓN DEL POTENCIAL DE CALENTAMIENTO GLOBAL
Mejor IC = Mejor utilización de los nutrientes
28%
MENOR EXCRECIÓN DE NITRATO Y FOSFATO
MENOS 0.57L
Requerido por 1,0 kg de pollo
MEJOR INGESTA DE AGUA = Mejor Salud Intestinal
Mejor calidad de la yacija
Mejor salud plantar
Más uso del agua eficiente y sostenible
Progreso de peso vivo, periodos de cría más cortos y menor producción de alimento y transporte=
MENOR USO DE LA TIERRA & MENOS TRANSPORTE
Mejora del I.C. = un pollo de 2,5 kg consume…
0.8 kg DE ALIMENTO MENOS
42%
MENOS ALIMENTOS SUPONE…
MENOS DE TIERRAS AGRÍCOLAS
requeridas para la producción de alimentos para la cría de pollo
ECONÓMICA AMBIENTAL SOCIAL
19 % MENOS DE CONSUMO DE ENERGÍA
18.3%
Para suministrar materias primas y alimento para pollos
Descubre más sobre cómo Aviagen® protege el planeta para las generaciones futuras VER ONLINE